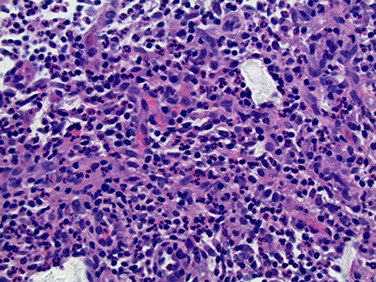
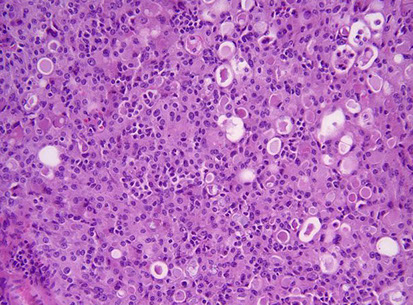

Breast
Breast Embryology
Breast Anatomy
Breast Histology
Invasive Breast Cancer
Reactive, Inflammatory and Nonproliferative Lesions
Biopsy Site Changes
Fat Necrosis
Reactions to Foreign Material
Mammary Duct Ectasia (Periductal Mastitis)
Lymphocytic / Diabetic Mastopathy
Granulomatous lesions
Idiopathic / Lobular Granulomatous Mastitis
Galactocele
Juvenile / Virginal Hypertrophy
Gestational Macromastia
Mondor's disease
Cysts
Metaplasia
- Apocrine metaplasia
- Squamous metaplasia
Cystic Neutrophilic Granulomatous Mastitis (CNGM)
Invasive ductal carcinoma
Invasive lobular carcinoma
Tubular carcinoma
Invasive cribriform carcinoma
Mucinous carcinoma
Medullary carcinoma
Invasive micropapillary carcinoma
Metaplastic carcinoma
Adenoid cystic carcinoma
Carcinoma with Neuroendocrine features
Carcinoma with apocrine differentiation
Invasive carcinoma with Osteoclast-like Giant cells
Lipid/glycogen-rich carcinoma
Pleomorphic carcinoma
Invasive carcinoma with choriocarcinomatous features
Hereditary breast carcinoma
Staging of breast cancer
Molecular classification of Breast Cancer
- Luminal A, Luminal B, HER2, Basal-like, Molecular apocrine, Claudin-low
Spindle Cell Lesions
UDH, ADH and DCIS
Columnar cell change and Flat Epithelial Atypia
Spindle cell carcinoma
- Fibromatosis-Like Spindle Cell Carcinoma (FLSCC)
Fibromatosis
Inflammatory myofibroblastic tumor
Myofibroblastoma
Nodular fasciitis
Spindle cell sarcoma
Columnar cell change
Columnar cell hyperplasia
Flat Epithelial Atypia (FEA)
Vascular lesions
LCIS and ALH
Fibroepithelial Lesions
Fibroadenoma (FA)
Complex FA
Juvenile FA
FA Change
Tubular Adenoma (TA)
Lactating Adenoma
Apocrine Adenoma
Mammary Hamartoma (MH)
Phyllodes Tumor
Perilobular hemangiomas
Hemangiomas
Venous hemangioma
Angiomatosis
Angiosarcoma
Papillary Endothelial Hyperplasia
Pseudoangiomatous Stromal Hyperplasia (PASH)
Other Mesenchymal Lesions
Lipoma
Angiolipoma
Granular cell tumor
Myxoma
Inflammatory Myofibroblastic tumor
Periductal stromal sarcoma
Primary breast sarcoma
Adenosis and Sclerosing Lesions
Miscellaneous Rare Lesions
Sclerosing Adenosis
Apocrine Adenosis
Microglandular adenosis (MGA)
Tubular Adenosis (TA)
Secretory adenosis
Blunt Duct Adenosis
Radial scars / complex sclerosing lesions
Papillary Lesions
Intraductal papilloma
Ductal adenoma
Pleomorphic adenoma
Adenomyoepithelioma
Collagenous spherulosis
Atypical papilloma / Papilloma with DCIS
Papillary DCIS
Encapsulated (intracystic) papillary carcinoma
Solid papillary carcinoma
Invasive papillary carcinoma
Amyloid tumor
Wegener granulomatosis
Lymphoma
Rosai-Dorfman disease
Nipple disorders
Accessory nipples
Squamous Metaplasia of Lactiferous Ducts (SMOLD)
Nipple adenoma
Syringomatous adenoma
Paget's Disease
Male Breast Lesions
Gynecomastia
Male Breast Cancer
Breast Pathology in Children and Adolescents
Microinvasive Carcinoma
Juvenile (Virginal) Hypertrophy
Juvenile Fibroadenoma
Juvenile Papillomatosis
Papillary duct hyperplasia
Secretory carcinoma
Axillary Lymph Nodes
Treatment Effects
Breast Embryology
Begin in 5-6th week as ectodermal thickenings along mammillary ridges (milk lines) between axilla and groin. Most regress.
Mammary (breast) bud forms around 15 WGA due to temporary sensitivity of mesenchyme around epithelial stalk to testosterone
- infiltrates down into mesenchyme and sprouts into mammary chords (solid epithelial columns, which then are encased by fetal papillary dermis (fibrous CT w/vessels).
-- breast bud secretes PTH-RP, which binds PTH-RP receptors of dermal mesenchymal cells, aiding in maturation
* supernumary nipples can be seen if the milk line doesn't make this downward migration; seen in ~3% of population (or more?)
Reticular dermis (++collagen) attaches breast parenchyma to skin, forming suspensory ligaments of Cooper.
20-32 WGA, parts of the mesenchyme form fat.
- Estrogen from fat cells surrounding the mammary chord and bud stimulate branching, but the male ductal system inverts in the presence of testosterone
32-40 WGA, due to mesenchymal paracrine effects, epithelial cords hollow branch out into lobuloalveolar structures.
- mammary ducts become lactiferous ducts
Nipples come from evagination (thus inverted in utero) of mammary pit (located where all lactiferous ducts come together) around parturition.
- begins to protrude after birth as areolar glands develop
- Colostrum can be secreted at birth b/c withdraw from placental/maternal sex hormones.
- Hematopoiesis in stromal mononuclear cells till 4 months postpartum
Ectopic breast tissue MC in the axilla, though can be seen anywhere on ant chest wall

Anatomy
L. mammae
Mammary glands with supporting structures embedded within fat with usual vessels, nerves and lymphatics
Usually between the 2nd and 6th ribs overlying the pectoralis fascia and retromammary space (a thin layer of fat that allows some breast mvmt)
- axillary tail of Spence is a portion of mammillary gland that extends towards axilla
- Mammary glands may extend into pectoralis muscle; may be significant when considering mastectomies in removing all breast tissue
Suspensory ligaments of Cooper are ligaments that attach the breast to the skin and support the glandular lobes and lobules
Breasts enlarge during puberty mostly due to increased fat deposition
The parenchyma (functional part) of the glands are formed from the lactiferous ducts, ultimately becoming mammary gland lobules
- each lobule is drained by a lactiferous duct, which dilates right beneath the areola in the lactiferous sinus (where milk accumulates)
-- ~18 separate lobes systems eventually reach nipple
- mammary glands are basically modified sweat glands bc have no capsule or sheath
- new glands are formed during pregnancy
- alveoli are the grape-like clusters found at the end of the ducts
The pigmented areolae surrounding the nipple contain lots of sebaceous glands which lubricate the nipple during lactation with an oily substance to prevent irritation
- there are no sebaceous glands in the nipple
Nipple instead has circular sm muscle sphincter which helps in milk secretion
Breasts get blood supply from the Lateral thoracic and thoracoacromial branches of the axillary artery, the medial mammary branches of perforating branches from the subclavian artery, and posterior intercostal arteries from the thoracic aorta
Axillary vein and a small amount from the internal thoracic vein drains the breast
Subareolar lymphatic plexus drains mostly (75-90%) into the axillary lymph nodes from the anterior/pectoral lymph nodes
- from there goes to the clavicular lymph nodes and further into the subclavian lymphatic trunk
Some of the medial breast quadrant drains to the parasternal lymph nodes
Lower breast quadrant may drain to the inferior phrenic lymph nodes below the diaphragm


Breast Histology
The wonder years
Estrogen in teenagers around puberty causes periductal CT to become more dense and elongate/branch.
- Lobuloalveolar and CT growth b/c of ovulatory E/P cycles
- Breast terminal differentiation induced (only) by prenancy
- Male breast has fibro-fatty tissue and ducts/ low cuboidal cells. Adults have branching ducts but no lobules.
Adult
Ducts, ductules, lobular acinar units in fibro-fatty (percentage changes w/age) stroma.
- Drain to collecting ducts, then becoming lactiferous sinus immediately before nipple.
-- Lactiferous sinuses close to nipple appear irregular and pleated, surrounded by stroma w/ ++ SM, collagen, elastic fibers
- Ductal systems (~5-10/breast) may intertwine, but don't connect.
Ducts lined by double cell layer: luminal epithelial cells and basal myoepithelial cells. **
- Luminal epithelial cells: simple cuboidal-columnar, light eosinophilic cytoplasm, uniform oval nuclei.
-- (+) cytokeratin 7, 8, 18, 19
- Basal myoepithelial cells (MEC's or MEPs): Discontinuous and variable appearance... flat w/ compressed nuclei to prominent w/ abundant clear cytoplasm to myoid spindly shape w/ darker eosinophilic cytoplasm (similar to SM cells).
-- (+) S-100, actins, calponin, SM myosin heavy chain, p63, CD10, cytokeratin 5/6, 14, 17, EGFR (? - is a marker for Basal-like tumors of TNBC)
Metastatic TNBC usually does not express ER/PR, GCDFP-15, or mammaglobin, but CK5/6 expressed in 62.3% and EGFR in 91%
Progenitor cells: stem cell-like, can turn into above 2 cell types, randomly interspersed throughout ductal system.
-- (+) basal cytokeratin CK5
Basal lamina: type IV collagen, laminin. Surrounds basal myoepithelial cells and separates from stroma.
Terminal duct lobular unit (TDLU): structural/functional unit of breast. Made of acinus, intralobular and extralobular terminal duct.
- secretion and transport
- birthplace of most breast dz. (even stuff called ductal really comes from the TDLU)
-- Solitary intraductal papilloma is the only lesion thought to solely derive from ducts
Large ducts: TDLU connects to subsegmental duct, which connects to the segmental ducts, then the lactiferous sinus and finally the collecting duct (below nipple)
Intralobular stroma (located between individual acini) loose and filled w/ various inflammatory cells
- Interlobular stroma (surrounds intralobular stroma) dense w/ ++ collagen, fewer cells.
Multinuclear giant cells may be found in extralobular stroma. Look bad, but no worries.
Lobules may be categorized (Type I - IV, by Russo) depending on various factors. Type I = immature, type IV in pregnant women.
-- Inc. # lobules/ # acinar units in preg., b/c of epithelial prolif. from hormone stim. Intra- and extralobular stroma dec. significantly.
--- Around parturition lumen size inc. and basal myoepithelial cells get stretched thin (hard to see), while luminal epithelial cells swell.
--- Luminal epithelial cells appear bulbous/ hobnail and stick out into lumen postpartum.
-- TDLU's atrophy in menopause, intralobular stroma becomes fibrotic
Ducts and lobules may undergo various histologic changes depending on pt's hormonal status (ie clear cell change and cystic hypersecretory hyperplasia in pregnancy)
- In pregnancy lobules increase in size and #, and almost entirely take up stroma
-- lobules first make colostrum (inc protein), then milk (inc fat and calories) about 10 days later when progesterone drops
- epithelial cells apoptose and lobules partially regress when lactation ends
- Lobules and lobes are NOT seen in non-pregnant mammary gland
Nipple/areola: keratinized stratified squamous; extends a little into lactiferous ducts.
Also w/ scattered clear cells, dubbed Toker cells (normal finding, not necessarily Paget's dz.)
-Orifices (pores) clogged w/ keratin when not lactating. # pores not dependent on underlying duct structure.
- (-) pilosebaceous units and hair, except at border, and may come in from dermis
-- Tubercles of Montgomery: lactiferous duct + sebaceous gland; become enhanced during pregnancy
Elderly
TDLU involutes and may become microcystic (not a fibrocystic lesion) and sometimes elastosis
IHC:
ER: alpha and beta subtypes
- ER alpha: nuclei of lobule > ductal cells (small % in both, scattered).
-- Inverse relation bwt. ER(+) cells and markers of cell prolif. (Ki-67) in premenopausal, usually do not occur together
-- # ER(+) cell inc. w/ age until menopause, varies w/ menstruation.
- Negative in myoepithelial cells
ER beta found in both epithelial and myoepithelial cells
PR: found in same nuclei as ER, no variation w/ menstruation.
Epithelial cells: (+) casein, α-lactalbumin, gross cystic dz fluid protein (GCDFP)-15, c-kit (CD117), keratins 8, 18, and 19, EMA,
- (-) CK14,
Myoepithelial cells: (+) S-100, actins, calponin, SM myosin heavy chain, p63, CD10, CD109, p75NTR (neurotropin receptor), cytokeratin 5/6, 14, 17
Endocrine cells: (+) chromogranin

Myoepithelial (MEP) Markers


Cross section at the level of nipple shows lactiferous ducts with a scalloped appearance, possibly related to the origin of segmental branches. The duct system resembles any other dichotomously branching system of glands where a single large duct successively branches down to its most terminal level. The lactiferous duct gives rise to segmental ducts, which in turn gives rise to sub-segmental branches and so on until a terminal duct lobular unit is formed. The large lactiferous duct is the site for solitary papilloma and duct ectasia with nipple discharge.

Cystic hypersecretory hyperplasia

As the lactiferous duct runs deeper into the breast tissue it branches out into segmental branches which are smaller but still lined by two layers (arrow): the luminal epithelial layer of cuboidal to columnar cells and an outer myoepithelial contractile layer.

This photomicrograph depicts a sub-segmental duct (arrow) giving rise to multiple “Terminal duct lobular units (arrowheads)” embedded in dense stroma. The TDLU are terminal units of the duct system.

Reactive, Inflammatory and Nonproliferative Lesions
Biopsy Site Changes
MC reactive breast lesion
Type of change depends on time since prcedure and type of procedure performed
- organizing hemorhage, fat necrosis and foreign body giant cell reaction and scarring typically seen, as in other places
Squamous metaplasic may completely replace glandular epithelium around bx site
Infarction esp common in papillary and fibroepithelial bx sites, and may obscure the true dx
Tissue marking devices cause different kinds of reactions:
- copolymer pellets (dissolve during processing) have fibrotic rim, few lymphos/eos, and later a giant-cell rxn surrounding an empty space
-- with time this plug is filled with granulation tissue and collagen
Cysts may form at biopsy site from displaced epithelial cells, which decrease with time and may be related to papillary lesions
- may cause misdiagnosis of invasive carcinoma
- should do stains for myoepithelial cell, which if positive indicates benignity
Fat Necrosis
Secondary to trauma (upper breast quadrant from seatbelt line in MVA) usually 1-2 wks prior, although no traumatic event identified in 1/2 of cases; fairly common cause of breast bx
Simulates carcinoma clinically (retraction, possible orange color from hemosiderin) and on imaging
- assoc c Weber-Christian dz
Gross: variegated yellow-grey with focal hemorrhage on sectioning
- may cavitate from liquid necrosis, form a thick fibrous scar, or remain as a cyst and have calcified walls (termed membranous fat necrosis)
Micro: architectural distortion, mass, calcifications
Changes with time: at first is hemorrhagic with indurated fat, and lipid-laden histiocytes and giant cells surrounding cystic spaces c calcifications and central areas of liquifactive fat necrosis
- may be difficult to do a frozen on bc of the large amount of liquefied fat
Later forms a hard mass with time from fibroblast prolif and collagen deposition (still may have the fatty-histiocytes and giant cells); hemosiderin should be present too
Reactions to Foreign Material
Firm nodules, usually caused by paraffin and silicone in implants
Fibrous capsule can form around the depositions, and the tissue may contract, deforming the tissue and causing pain requiring implant removal and capsulectomy
- capsule will be fibrous with inflam, FBGCs, fat necrosis, granulation tissue and histiocytes
- can mimic invasive breast ca by imaging
- silicone can become incorporated within the capsule, making oval cystic spaces; seems to imitate synovial lining sometimes (synovial metaplasia), aka pseudoepithelialization, or capsular synovial thyperplasia
- synovial metaplasia probably due to mechanical forces
-- silicone can even spread hematogenously around body

Collagen plug in bx cavity
http://www.pathologyoutlines.com/topic/breastforeignbodyreaction.html

Fat necrosis: A. FNA (see lipid drops, foamy macs, mngcs. B. necrosis, foamy macs, inflam , mngcs

Reaction to foreign material

Mammary Duct Ectasia (Periductal Mastitis)
See periductal inflam (c lots o plasma cells) and fibrosis and ductal dilatation
- usually in peri-/postmeopausal women; can sometimes present c pain, thick white nipple discharge and retraction, or a mass (mimics cancer)
-- may be due to a local response to stale colostrum
- rads shows ductal calcifications, mimicking DCIS
- found in 30-40% of women >50 yo (at autopsy); but less common to present clinically
- 20% have thick white secretions
Starts out in a single subareolar duct, causing thick, dilated ducts with pasty-brown secretions (looks like comedo necrosis of DCIS) with fibrotic stroma
Micro: chronic inflam and fibrosis around an ectatic duct filled c inspissated debris; thick fatty-material in ducts, lots of plasma cells in the walls, foamy histiocytes eat up the fat material in the walls and can also contain lipofuscin ("ochrocytes")
- lumen also filled with inspissated secretions, leading to lipid-laden macrophages
- if duct ruptures, get rxn with plasma cells, lymphos and macros with granuloma; may be a considered a form of fat necrosis
- duct lumen may get obliterated when the periductal fibrosis is strong; in which case they become surrounded by a "garland pattern" of tubular structures
Ectasia is a disorder of extralobular ducts, whereas cysts come from the TDLU; can also do elastic stain, bc ducts have elastic tissue but cysts don't

Mammary duct ectasia
http://www.breastdiseases.com/slides/ben28.htm
Lymphocytic / Diabetic Mastopathy
Seen in diabetics (type 1 or 2) and other autoimmune dz's (ie Hastimotos) in young-/ middle-aged women and even in men
- find palpable breast lesion present on mammo; can be multiple and bilateral (looks worrisome for ca, but no inc risk)
- lymphos are usually B-cells
See dense keloidal fibrosis (may be difficult to bx!), lobular atrophy and sclerosis, periductal, perilobular and perivascular infiltrates, and epithelioid myofibroblasts in stroma (may look like invasive ca)
- sclerosing mastitis may be part of IgG4-related sclerosing diseases
Px: may recur in same or other breast
- not at inc risk of breast ca
Diabetic mastopathy

Granulomatous lesions
Similar appearance to granulomas in other parts of body; non-caseating and confined to lobules
Sarcoidosis: rarely involve breasts, but can look cancerous
- have non-necrotizing granulomas c GCs in interlobular and intralobular stroma
- is a dx of exclusion; must differentiate from idiopathic granulomatous mastitis as well
Idiopathic / Lobular Granulomatous Mastitis
- uncommon with unknown pathogenesis, but related to recent pregnancy in young women
- see lobulocentric granulomas with neutrophils (which may create microabscesses due to high number)
-- true caseous necrosis not seen
also a dx of exclusion
may tx c roids
Galactocele
Uncommon; occurs following abrupt lactation cessation
- find a milk filled cavity beneath areola which may leak into surrounding tissue and cause lipogranulomatous reaction
-- histiocytes may eat up all the milk
Juvenile / Virginal Hypertrophy
Rapid enlargement of 1 or both breasts, usually asymmetric, causing the kid to freak out
- looks like gynecomastia on histo
Gestational Macromastia
Less common than Juvenile Hypertrophy; starts in early pregnancy and both breasts enlarge rapidly causing them to be edematous, erythematous and painful and may ulcerate
Mondor's disease
Phlebitis of the thoracoepigastric vein
Uncommon; affects women ages 30-50 yo
Clinically see a tender, cord-like sub-q mass
See phlebitis and periphlebitis with varying thrombosis on histo
Cysts
Fluid-filled round structures that can range from microscopic to grossly visible
- derived from TDLU from dilatation and unfolding and coalescence of lobular acini
Have an inner (luminal) epithelial layer and an outer myoepithelial layer
- epithelium may be thin to absent or may have apocrine metaplasia
-- may have calcifications from milk of calcium, calcium phosphate/apatite or calcium oxalate
May be confused with ductal ectasia ([+] elastic stains around ducts, but not cysts)
May also be confused with flat epithelial atypia and cystic hypersecretory carcinoma
Biopsies may not accurately represent these regions (?)
Cysts without proliferative changes have a relative risk of 1 for developing cancer
Proliferative cysts without atypia (intraductal epithelial hyperplasia, sclerosing adenosis, peripheral papillomas (not central papillomas in nipple), radial scars and complex fibroadenomas) have a relative risk of 1.5-2x for invasive ca

Metaplasia
Apocrine metaplasia
Enlarged epithelial cells with abundant granular, eosinophilic cytoplasm which can have apical luminal blebbing or snouting, supranuclear vacuoles or eosinophilic granules
- nuclei are variable in size with prominent nucleoli
- may be simple or in many layers and can appear papillary (papillary apocrine change)
Can look worrisome, but no inc risk of invasive ca
IHC:(+) ER - (-); bcl2 - (-); androgen-receptor (+), GCDFP-15 (++)

Apocrine metaplasia
http://webpathology.com/image.asp?n=3&Case=284
Squamous metaplasia
(aka Zuska disease): much less common than apocrine metaplasia (?)
- can be seen around biopsy sites, and also in cysts, usual ductal hyperplasia, intraductal papillomas, benign phyllodes tumors, fibroadenoma and gynecomastia
- see keratinizing squamous metaplasia of the nipple ducts
-- keratin plugs up ductal system and may cause duct to burst with ensuing granulomatous rxn
Glands stuck in these areas can undergo squamous metaplasia causing it to express p63
Cystic Neutrophilic Granulomatous Mastitis
Simulates malignancy clinically and radiographically
- assoc c Corynebacterium kroppenstedtii infx
- occurs in reproductive age women with hx of pregnancy and presents as a palpable mass that can be painful
Micro: lobulocentric granulomas with lots of neutrophils, usually lining empty "cystic" spaces of dissolved fat
- the cystic spaces contain rod-like bacteria on Warthin silver stain
The Corynebacterium require a special growth media that requires prolonged incubation to grow
- may detect with MALDI-TOF MS or16S rRNA and rpoB gene sequencing
Tx: tetracycline (prolonged abx use)
Cystic Neutrophilic Granulomatous Mastitis (CNGM)
UDH, ADH and DCIS
Usual Ductal Hyperplasia (UDH)
Benign
Proliferating epithelial cells bridge twistily across and fill the lumen, making it appear irregular with overlapping nuclei
- mixed population of cells, including luminal/epithelial and MEP cells
- can include apocrine metaplastic cells
- may appear solid, fenestrated, or micropapillary
-- micropapillary structure also seen in gynecomastia
Cells arranged in disorganized fashion (do not polarize), have unclear borders, may swirl, and are polymorphic
- can see foamy histiocytes, calcifications and necrosis
- surrounding stroma should be normal (no inc in fibroblasts, elastosis, or monos)
Low prolif rate, variable (mosaic) ER, mosaic CK5/6
EXCEPTION: Basal-like DCIS can mimic UDH, with HMWK staining in a diffuse or patchy pattern, although the neoplastic cells usually have high grade nuclei with abundant mits and central necrosis, and can be negative for ER/PR
- usually no genetic abnormalities (those with abnormalities are different from more malig breast dz)
Assoc c 2x inc risk of breast ca in either breast, esp c (+) FamHx of breast ca
UDH


Peng Y. Update on Immunohistochemical Analysis in Breast Lesions. Arch Pathol Lab Med 2017
Atypical Ductal Hyperplasia (ADH)
Neoplastic cells similar to DCIS; confined to ducts and lobules, proliferation of low-grade monotonous luminal cells c significantly inc risk of breast ca
- can dx ADH if meets criteria for DCIS but involves <2 ducts, or is <2 mm
Cells are small and uniform with well-defined borders
- polarize around lumen (though some cells may appear UDH-like)
- can see uniform layers of cells, cribriform patterns, and baseball bat (thicker at the luminal end) papillae
Usually dx'd when DCIS considered a possibility, but not enough of it present to dx for sure; thus another bx would probably show DCIS
- some use 2 cystic spaces as the cutoff; some 2 mm for calling ADH
Low prolif rate, strong, diffuse ER, negative CK5/6
Similar to DCIS, has loss of 16q and 17p and gain of 1q (14)
4-5x inc risk of breast ca in either breast; doubled c (+) FamHx breast ca
Tx: close f/u; possibly tamoxifen and surgical excision (?; 15% end up showing DCIS) but no radiation
ADH

Ductal Carcinoma in situ (DCIS)
Has widely variable features, but similar to ADH have neoplastic cells confined to ducts and lobules
Most present as microcalcifications
- 30% present radiographically as soft tissue density +/- calc or as architecturally altered
-- few present as a mass, Paget's dz, or another abnormality
Historically grouped into comedo, cribriform, micropapillary, papillary, and solid types
- now grouped into 3 grades based on nuclear features and necrosis
Things to look for: nuclear grade, necrosis, polarization, architecture
Low grade
Small, well-defined membranes; uniform; homogenous chromatin and inconspicuous nucleoli
- slightly inc N:C; few mits; +/- hyperchromasia
Cells polarize around cribriform lumens
Rarely has comedo necrosis
IHC: Diffuse strong ER / PR; low prolif rate; no HER2 amp; membranous p120, negative CK5/6
- ER status only thing used clinically (for tamoxifen tx)
loss of 16q and 17p; gain at 1q
Tx: complete local eradication and rads (at current location)
- assoc c 10x risk invasive ca in same breast (vs bilat in ADH)
Intermediate grade lies somewhere bwt Low and High grade
High grade
Large, pleomorphic nuclei; vesicular / coarse chromatin; frequent mits and comedo necrosis
- cells may not appear too organized (like UDH?)
Stroma surrounding lesion c inc vessels
Commonly have mutated p53, causing p53 to accumulate
Sometimes may have a few (+) CK5/6 cells
Loss at 11q; 14q; 8p and 13q; gains at 17q, 8q and 5p
Apocrine DCIS
Cells c abundant eosinophilic cytoplasm and may be low / intermed / or high grade
May extend into lobules and areas of sclerosing adenosis
Easier dx on high-grade (vs low-grade) lesions
Cystic hypersecretory DCIS
Cysts filled c thick liquid
Micro shows homogenous eosinophilic cytoplasm resembling colloid from thyroid
focal (+) mucin stain in epithelial cells; negative in actual cyst
Generally DCIS more likely to recur if in women under 45 yo; high grade; comedo necrosis; larger size; (+) margins
- margins are most important factor!
14-60% of low-grade DCIS progresses to infiltrative ca
USC-VNPI may predict recurrence
10-15% of DCIS pts have (+) lymph nodes
DCIS Tx: key is to prevent local recurrence
- mastectomy cure rates ~100%, but may be overtreatment (esp c small lesions)
Radiation following excision reduced local recurrence by 50%; further tx c tamoxifen further dec risk of recurrence
50% of recurrences are DCIS; half are invasive
DCIS vs LCIS
can share similar features:
- both can have small cells with monomorphic nuclei, intracytoplasmic vacuoles, solid growth pattern; comedo necrosis, apocrine features, pseudocribriform pattern
- LCIS can be in ducts; DCIS can be in lobes
Both can coexist in same breast
Poor cellular adhesion and intracytoplasmic vacuoles favor LCIS
Cohesive growth, lack of intracytoplasmic vacuoles and cell polarization favor DCIS
DCIS vs Invasive carcinoma (see microinvasive carcinoma below)

Low-grade DCIS

Examples of usual ductal hyperplasia (A and B), atypical ductal hyperplasia (C and D), and basal-like ductal carcinoma in situ (E and F) (hematoxylin-eosin, A,C, E]; CK5, [B, D, F]).
- the basal-like DCIS (E and F) was triple negative
High-grade comedo DCIS

Comedocarcinoma
Necrotic cell membranes calcify and are detected on mammography as clusters or linear and branching microcalcifications
- extensive lesions can be palpated as a vague nodule
- considered a subtype of DCIS
Micro: solid sheets of pleomorphic cells c high-grade nuclei and central necrosis
- commonly see periductal concentric fibrosis and chronic inflam
Risk of transformation much higher than non-comedo DCIS
Columnar cell change and Flat Epithelial Atypia
Columnar cell change
Enlarged TDLU; dilated acini c irregular contour
- 1-2 layers of columnar cells c long, oval nuclei arranged regularly with normal-looking nuclei/nucleoli (rare mits)
-- "picket fence" appearance
Can be seen blebbing stuff off into lumen
Can see calcifications as well
(+) CK 8/18/19 (LMWK), ER, PR, bcl-2
(-) CK 5/6 (LMWK) [can't be used to dx atypia], low Ki-67
2x inc risk of breast ca
Columnar cell change

Columnar cell hyperplasia
TDLU's also irregular and dilated
- in contrast to columnar cell change have >2 layers of columnar cells
-- may find small papillary lesions with these columnar cells
If complex architecture seen (bridges, fenestrations, polarized papillae), better to dx ADH or DCIS
- crowding and overlapping impart appearance of nuclear hyperchromasia
Blebbin is more prominent than columnar cell change; up to appearing hobnailed
- luminal calcifications normal (look like psammoma bodies)
(+) CK 8/18/19 (LMWK), ER,PR, bcl-2
(-) CK 5/6 (LMWK) [can't be used to dx atypia], low Ki-67

Flat Epithelial Atypia (FEA)
Enlarged TDLU lined by atypical cuboidal to columnar cells
- monomorphic round - oval nuclei appear similar to DCIS; looks bluer than normal TDLUs on low power
- have high N:C, nuclei marginated and clumped, and not arranged perpendicular to BM
- nucleoli variably prominent
Must distinguish from apocrine lesions (metaplasia) which appears similar but has more abundant, granular, eosinophilic cytoplasm (lower N:C), does not have as much blebbing or hobnail appearance, and is ER/PR negative
Rare mits
Commonly appears with ADH, low-grade DCIS, and tubular ca
- may be precursor to these neoplasms; dx warrants further levels on current specimen to look for ca
- assoc c other breast neoplasms (found in 1/3 of breasts excised with this dx)
Blebbin can also be prominent; and intraluminal calcs can also look like psammoma bodies
"Flat" = lack of complex architectural patterns
- Does not have club-shaped micropapillae, cellular bridges, arcades or sieve-like fenestrations
-- if there are papillae or fenestrations the cells do not polarize around them, but are disordered
Surrounding stroma can have lymph infiltrate
(+) CK 8/18/19 (LMWK), ER/PR (strong nuclear), bcl-2 (strong cytoplasmic)
(-) CK 5/6 (LMWK) [can't be used to dx atypia], low Ki-67
Has loss of 16q (like low-grade DCIS and tubular ca)
- Rosen triad: FEA, LG-DCIS, and tubular ca
Very low rates of recurrence and progression to invasive breast ca
FEA

LCIS and ALH
Small, loosely cohesive epithelial cells in TDLU
- differ in degree of neoplastic cell involvement
- commonly occur bilaterally
- may be the same entity (lobular neoplasia)
Loss of E-cadherin is one of the most consistent alterations in lobular lesions, although it can stain MEP cells in addition to epithelial (luminal) cells
- p120 catenin has membranous staining in ductal lesions and diffuse cytoplasmic staining in lobular lesions
Lobular Carcinoma In Situ (LCIS)
found in up to 4% of breasts in premammographic times; biopsy done for microcalc seen in tissue around the lesion
- more common in younger women (~45 yo; premenopausal)
Up to 30% bilateral; multicentric in unilateral breast in 80%
Acini filled and distended with solid proliferation of loosely-cohesive small cells with small, uniform, round nuclei with homogenous chromatin and inconspicuous nucleoli
Cytoplasm pale and lightly eosinophilic and have mucin vacuoles
- vacuoles can be very small (requiring a mucin stain for viz) to very large (cells appear as signet ring cells)
In terminal or extralobular ducts in 75%, growing in pagetoid manner (can sometimes see original epithelial layer underneath)
- may form "clover leafs"
- Mits infrequent
LCIS = >50% acini of a lobule filled with neoplastic cells
ALH = <50%
Type A: classic form just described (small, uniformly monotonous)
Type B: larger, abundant cytoplasm, nuclear and cellular polymorphism and prominent nucleoli and can have comedo necrosis
- A and B can coexist in same lobule
Pleomorphic LCIS: LCIS with highly atypical cells (larger pleomorphic nuclei with irregular membranes and prominent nucleoli)
- pleomorphic LCIS more often has comedo necrosis and calcification
- vs common LCIS (A and B), has (+)ER, possible HER2 and p53, higher Ki-67
- pleomorphic LCIS and florid LCIS can mimic high-grade DCIS, and loss of E-cadherin is critical for differentiating between them
Other types of LCIS can appear to have clear-cell change, rhabdomyoblast appearance, or cohesive or pseudocribriform pattern (mimicking DCIS)
IHC: (+) ER, HMWK/34βE12 (vs DCIS), p120 catenin (cytoplasmic in LCIS, membranous in DCIS)
(-) HER2, p53, low Ki-67, loss of E-cadherin (thus discohesive)
- loss of E-cadherin clutch in differentiating from DCIS; but must watch out for intermixed normal cell population staining for E-cadherin (can throw you off) - sometimes E-cadherin can be aberrantly expressed in lobular lesions as well
Loses 16q and gains 1q (also in low-grade DCIS)
10x inc breast ca risk in bilateral breast c LCIS; ALH 4-5x inc risk
- 1% per annum for 25 years, more likely to get ca in ipsilateral breast in first 10 years
LCIS generally thought of as a breast ca risk and not a direct precursor
- but pts c LCIS more often get invasive lobular ca c same genetic alterations; so may not always hold true
Classic form Tx: Observation +/- tamoxifen
- not necessary to report margins (?)
Pleomorphic Tx: treat as DCIS, need negative margins
- some argue for breast tissue excision for this type, comedo necrosis, and classic form with ADH
Poor fixation may cause discoehiveness similar to DCIS
Normal myoepithelial cell layer may mimick pagetoid spread
Right. Examples of pleomorphic lobular carcinoma in situ (A and B), florid lobular carcinoma in situ (C and D), and lobular carcinoma in situ (LCIS) (E through G). H, LCIS with associated invasive lobular carcinoma (hematoxylin-eosin, x200 [A] and x400 [C and E]; E-cadherin, x200 [B] and x400 [D and F]); p120-catenin (pink) and E-cadherin (brown) double stain, x400 [G and H]).
Peng et al. IHC analysis in Breast Lesions. Arch Pathol Lab Med


LCIS c targetoid (bulls eye)



Fibroepithelial Lesions
Fibroadenoma (FA)
MC benign lesion of female breast
- MC in women under 30 yo
Present as single, firm, mobile mass <3 cm or by mammo
Giant fibroadenoma shows racial predilection for black adolescent women
Easily removed by surgery
- are grossly firm, well-circumscribed, bosselated with tan-grey lobulated interior and slit-like regions
Well-circumscribed yet unencapsulated on micro
2 (often coexisting) patterns possible:
1) intracanalicular - with distorted, compressed glands due to proliferating stroma
- can be misinterpreted as phyllodes tumor or intraductal papilloma
2) pericanalicular - stroma surrounds glands but lumen remains open
Can have normal 2 cell layer of epithelium or any kind of prolif changes
Stroma is often spindle shaped with elongated nulei and rare mits
- myxoid fibroadenomas seen c Carney's syndrome
- if stroma is really hypercellular, can dx cellular fibroadenoma
MNGCs can look bad, but are benign (sometimes seen in normal breast)
Infarcts are MC during pregnancy and lactation
ER-β (+) in stroma
- directly assoc c youth and stromal cellularity
- ER-α expression is variable
- PR (+) in both epithelium and stroma
- stroma has CD34+ fibroblasts and factor XIIIa+ dendrophages
- GCDFP-15+ in metaplastic cells in FA c apocrine metaplasia
Genes: polyclonal epithelium and stroma
Tx: observation (after bx confirmation)
- may have 2x inc breast ca risk
-- ADH in context of fibroadenoma has less inc breast ca risk than in normal breast tissue
Complex fibroadenoma (FA)
Fibroadenomas with cysts >3 mm, sclerosing adenosis, epithelial calcs, or papillary apocrine change
- have 3x inc relative risk for breast ca than regular fibroadenomas
Tx: shelled out, can do wide excision if worrisome features
Juvenile FA's
FAs in younger pts c inc cellularity in stroma more inc epithelial hyperplasia than regular FAs
- have evenly distributed stromal hypercellularity and inc # TDLUs in any given area
- may also grow more rapidly
FA change (FA hyperplasia)
Has histo changes similar to FAs, but no mass is formed
Tubular Adenoma (TA)
well demarcated, similar in histo to FA (may be related to FA), occurs in young women
Grossly softer and more brown than FA
Has closely packed glands with little stroma in between
- not known to be pre-malignant
Lactating adenoma (Nodular Lactational Hyperplasia) [LA/NLH]
Only in pregnancy, though can be seen in ectopic breast tissue in the axilla or elsewheer
Well circumscribed, hyperplastic lobules
- grossly will be gray and tan and sometimes necrotic
Micro: proliferated glands lined by cuboidal cells that actively secrete milk
Apocrine Adenoma (AA)
Nodular aggregate of ducts/ glands with prominent apocrine change and apocrine cysts
Mammary Hamartoma (MH)
aka fibroadenolipoma, adenolipoma
Seen in premenopausal women
Well-demarcated density surrounded by radiolucent halo on mammo
Grossly smooth, well-circumscribed, oval mass
Micro: Well circumscribed but unencapsulated nodule with ducts, lobules, fibrous stroma and fat in whatever proportion
- may have apocrine metaplasia or pseudoangiomatous hyperplasia, or sm muscle (myoid hamartoma), or cartilage (chondrolipoma)
B/c imitates normal breast, impossible to dx w/o clinicoradiologic correlation
Phyllodes tumor (PT)
-ie cystosarcoma phyllodes
rare (<1%), biphasic lesion
occur in older age than FA (usually in 40s);
- may be derived from FA's
Clinically see rapidly enlarging mass; higher incidence in Latino women and Asian Americans
Larger than FA (4-5 cm)
- the larger the lesion, and presence of necrosis the higher likelihood of malig
Grossly, multinodular circumscribed masses of whorled gray tissue
- may see clefts, cysts and cauliflower like appearance
Histo: Periductal stromal hypercellularity (and periductal stromal heterogeneity, having areas with more hypercellular stroma and areas with more hypocellular stroma) and prominent intracanalicular growth pattern
- Maple-leaf appearance from stroma juttin into cystic spaces
- UDH common
Malig potentional based on stromal cellularity, stromal atypia, stromal mits, tumor margin, stromal overgrowth (one 4x field of pure stroma, no epithelium) - all are subjective
The epithelium is polyclonal and the stoma is clonal (vs most other fibroadenomas)
Recurrence more likely in malig lesions; usually are more atypical
Mets uncommon (up to 1/4 in malig lesions), but usually are composed of stroma that goes to lungs and bones
IHC: (+) stromal CD34, nuclear B-catenin, ER
- neg: CK903, SMA, desmin
- Ki-67, p53, and CD117 (c-kit) predicative of malig (c-kit of recurrency)
Call fibroepithelial lesion c inc stromal cellularity if uncertain of PT, but to get more breast tissue excised
DDx: Cellular FA / juvenile / PASHy FA, sclerosing lobular hyperplasia
Tx: wide excision
- axLN eval not usually done (mets to axLN <1%)
- MC mets to bone and lung (up to 25% if malignant!)
-- more benign course when occurs in younger pts
Px: >70% Benign, although even b9 tumors can recur (up to 20%)
- benign PTs may be tough to differentiate from cellular FAs
- malignant PTs have high mits (>10 mits / 10 hpfs) and is highly pleomorphic; but mits in general aren't necessary to dx
-- malignant/borderline phenotype: +1q, +5p, +7, +8, -6, -9p, -10p, -13
-- malig PTs must be ddx'd from spindle cell carcinomas and primary breast sarcomas
- malignant PTs act more like sarcomas and tend to met to the lung instead of the LN (as in carcinomas)
Fibroadenoma

Fibroadenoma


Myxoid-type FA assoc c Carney syndrome

Juvenile FA

Tubular adenoma (TA)

Lactating adenoma


Mammary Hamartoma

Phyllodes tumor


Phyllodes tumor

Adenosis and Sclerosing Lesions
Intro
Lesions may be confused with invasive ca (esp low grade types)
Adenosis: benign lesions in breasts with inc # mammary gland units
- simple adenosis: inc # lobular acini w/o lobular architecture distortion
Sclerosing: glands trapped and distorted by CT
- ie radial scars, complex sclerosing lesions
Sclerosing adenosis (SA)
Lobulocentric benign gland/tubule prolif with stromal prolif which compresses and distorts glands; occurs at the TDLU
- centrally cellular c 2 cell layers, dense stroma, no mits or necrosis
- usually incidental finding (seen in up to 1/3 benign breast bx's), but can cause palpable / mammo-visible lesion (in which case called nodular adenosis or adenosis tumor)
- glandular ME cell layer may be difficult to see in some places on H&E, but should be visible c IHCs (smooth muscle heavy chains, p63, calponin, etc etc)
Glands most compressed in center of lesion, resulting in swirly mass of solid cell cords, and dilate as they move away from the center
- can often see perineural invasion
- calcs are common
On low power should be well circumscribed and lobulocentric
Can have invasive or in situ ca inside, which usually req IHCs to dx correctly
IHC: (+) Smooth Muscle Myosin Heavy Chain (SMMHC) and P63 most sens and spec for ME cells
Assoc c up to 2x inc risk breast ca
1. Visscher DW et al. Sclerosing adenosis and risk of breast cancer. Breast Cancer Res Treat. 2014 Feb; 144(1):205-12
Sclerosing adenosis


Large,central area of Sclerosing Adenosis (arrow), with diameter larger than the normal lobular units pictured to the right (arrow heads). This SA would be classified as Proliferative Disease Without Atypia.
A lobular unit with sclerosing adenosis but without significant increase in its diameter (arrow): compare with normal lobular unit (arrow heads). This would be classified as Non-Proliferative changes
Apocrine adenosis
Benign lesions looking like sclerosing adenosis but with apocrine metaplasia
- throw atypical in front of it if apocrine cells have >3 x variation in nuclear size
-- not too sure about differentiating this atypical lesion from apocrine DCIS within sclerosing adenosis, but if found involving or near the margin should reexcise in order to see what it looks like outside of sclerosed zone
- apocrine cells in sclerosed zone can look invasive; thus should get IHCs before dx'ing
Atypical and regular-style apocrine adenosis has unknown (but probably low) cancer progression risk
Microglandular adenosis (MGA)
Small, round (unsquished), uniform glands proliferating non-lobulocentrically that have a reddish secretion in their lumens
-infiltrates within mammary stroma and adipose tissue, and is surrounded by type IV collagen (vs negative in tubular ca) and thus is laminin positive
- can also present on mammo or as palpable lesion, mimicking carcinoma
Glands have BM, but no outer ME layer; just a single layer of cells (thus p63 and SMA negative [normally stain ME cells?])
IHC: (+) S100, pancytokeratin, cathepsin D, laminin (bc has BM)
(-) EMA, ER, PR, and GCDFP-15
Calcium, and eosinophilic PAS-(+) [diastase resistent] secretions usually found in lumen
Atypical version exists with cribriforming nests, bridges, cytologic atypia and loss of luminal gunk, can turn into carcinoma (invasive and in situ)
- retains IHC characteristics of benign MGA
DDx: tubular ca (has stelllate appearance and larger tubules, is angulated, snouts into lumen, no BM or luminal gunk, is S100 (-), ER/PR and EMA (+), and is not surrounded by type IV collagen)
Tx: complete excision c negative margins
Px: Does not met

Microglandular adenosis




Microglandular adenosis (MGA, I -L) negative for ER (J), and p63 (K), but positive for S100 (L)

Primary Acinic Cell Carcinoma of the Breast
Identical to salivary gland counterpart, c serous differentiation
- have diffuse infiltrative growth pattern of small glandular structures made of cells c coarse granular or clear cytoplasm that look like acinar cells of the salivary glands or Paneth cells
- uncommon, < 20 cases reported
Gross: usually well-circumscribed, can be infiltrative, with a gray pink and hemorrhagic cut surface; 2-5 cm
Micro: monotonous prolif of cells c abundant finely granular weakly eosinophilic or clear vacuolated cytoplasm, central round nuclei and prominent nucleoli that look like acinic cells of salivary gland
- can have up to 15 mits / 10 HPFs
Tubular adenosis (TA)
Not as circumscribed as SA (only vaguely lobulocentric)
Messy prolif of long, branchy tubules, c 2 layers of cells
- looks round on cross section
- also has luminal gunk and calcs
Can have DCIS in it; would need IHC to be sure
Tx: observation
Secretory adenosis
similar architecture to MGA, but has ME cell layer around the tubular structure
Blunt duct adenosis
Can be either:
1) UDH-ish lesion in lobular acini and terminal ductules
2) Enlarged lobules with dilated acini with blunt contours lined by columnar cells (now usually called columnar cell change)

Radial scars / Complex Sclerosing lesions
Forms irregula mass, can be spiculated like invasive ca on mammo, grossly and on micro
Radial scars have central sclerosed core c entrapped glands surrounded by (variably present) outer ME layer which radiate out
- peripheral ducts / lobules radiate circumferentially around central core
May have 2x inc risk breast ca
Tx: none (if no ca found inside)
Complex sclerosing lesions
Fibrotic / fibroelastic stroma c glands trapped inside (also with outer ME layer), are often larger and do not have the orientation of radial scars
Ducts / lobules have varying adenosis, hyperplasia, papillomas and cysts and are less organized than radial scars
Radial scar

Distinguishing papillary lesions of the breast

Papillary Lesions
Generally, digitish projections with fibrovascular cores
Distribition (and, generally, the presence of) ME cells useful in dx'ing
Should open specimen grossly c scissors until papillary lesion exposed, to avoid missing lesion
Frozen should not be performed on papillary lesions bc difficult to correctly dx, and freezing destroys its architecture
Intraductal papilloma (IP)
B9 papillary lesions c fibrovascular cores lined by MEP and epithelial layers; can be central (solitary, and in large ducts) or peripheral (multiple and involving TDLU); MEP layer always there (use calponin, p63 etc)
- presents c bloody nipple discharge
- epithelium may have varying degrees of hyperplasia (UDH to DCIS); see lots of apocrine (sometimes squamous [assoc c infarcts]) metaplasia
- collagenous spherulosis may be present
2 groups: Central and Peripheral
Central lesions usually have nipple discharge, which can be bloody, or present as subareolar mass, arborizing fronds
- usually small (<1 cm), bosselated, pink, grossly circumscribed nodules in a dilated duct / cyst
Peripheral type in younger pts and have nipple discharge less often; usually present as calcs on mammo
- more assoc c atypia
If so much fibrosis is present that papillary architecture disrupted, can call sclerosing papilloma
- can differentiate from infiltrating lesion by presence of ME layer
Tx: excision (? - questionable in benign lesion, but better to be on safe side [?])
Px: 2x inc risk breast ca with multiple lesions (or 0-25% inc?); no inc risk if only a solitary lesion
Ductal adenoma
Epithelial cells in nests and glands surrounded by thick capsule
- has ME layer
- generally thought of as really sclerotic version of ip with obliterated architecture
Pleomorphic adenoma
- aka benign mixed tumor
Similar to salivary gland neoplasm
- made of mix of myo- / epithelial cells in mucinous and chondromyxoid stroma
May be a variant of papillary adenoma
Adenomyoepithelioma
aka adenomyoepithelial lesion
Benign multinodular, lobular lesion with epithelial and ME layers
Biphasic architecture with ductal and MEP cells (hence the name...)
- Clear to spindly ME cells form majority of lesion and surround tubular structures lined by ductal epithelial cells
Variant of IP
- can have lobulated, tubular, papillary or mixed patterns
- can be difficult to differentiate from IP if papillary pattern predominates
IHC: CK5 and MEP markers highlight the dual population of cells
Tx: excision (recur if not completely excised)
Px: may recur locally
- malignant transformation is extremely rare, but when happens is seen in both the ductal epithelial and MEP components
Collagenous spherulosis
Benign. Commonly in intraductal papilloma or sclerosing adenosis, but also in many other lesions (rarely LCIS)
- may bee seen in assoc c salivary gland tumors
See hyaline, eosinohilic, acellular spheres in lumen composed of Type IV collagen and laminin +/- calc
- though has no mucin (negative for Alcian blue)
Atypical papilloma (AP)
aka
IP with ADH/LG-DCIS
Papillae with foci of ADH or DCIS, but are otherwise normal papillae
- presence of population of monotonous cells with cytologic and architectural features of LG-DCIS
- MEP layer scant or absent, CK5/6 (or ADH-5 [ the breast marker cocktail]) absent, and uniform ER (+) in atypical regions
Differentiating bwt IP with ADH or IP with LG-DCIS depends on the size of the atypical cell population
- call ADH if smaller than 3 mm, LG-DCIS if 3 mm or larger
Tx: Complete excision and careful f/u
Px: may have similar to slightly inc risk of breast ca (4-5x) ipsilat
Right.IP with florid UDH (A though D). C is CK5, and D is p63t
Papillary DCIS
Lesion is DCIS growing with papillary architecture, without any benign papilloma present
- have no ME layer (should be present at lesional border, or else is considered invasive), grow uniformly perpendicular to cores, have dark nuclei, delicate (less fibrotic) stroma, absent apocrine metaplasia
- have dimorphic-globoid cells that are not myoepithelial cells
Intraductal Papillary Carcinoma
De novo, in situ papillary malignant processes without a recognizable benign IP in background
Micro: slender fibrovascular cores covered by single layer of monotonous neoplastic cells without the presence of MEP
- however, MEP cells can be focally retained at periphery of lesion (?)
- nuclei usually low to intermediate nuclear grade and usually have strongly positive ER, PR and luminal cytokeratins
Encapsulated (intracystic) papillary carcinoma (EPC)
Variant of intraductal papillary carcinoma; as name suggests, presence of papillary carcinoma within a cyst or capsule
MC in elderly women close to areola c discharge
Grossly, a bosselated mass in an enclosed space
Micro: fine fibrovascular cores covered by neoplastic cells surrounded by a fibrous capsule
- see papillary carcinoma in this space, possibly invading into capsule
- ME layer will not be present at periphery of these lesions or in the papillae
- the nuclei are usually low to intermediate grade
- high-grade EPCs have marked nuclear pleomorphism and inc mits and will be negative for hormone receptors and tend to be larger and assoc c stromal invasion
DDx: intraductal papilloma +/- secondary DCIS, intraductal papillary ca
Tx: same as DCIS (staged as pTis)
- may see invasion through the capsule (should measure extent of invasion); though does not invade as often as solid papillary ca
-- may be a low-grade invasive ca c expansile growth
- high grade EPCs are rare (3% of EPCs) but should be staged and treated as invasive carcinomas as many pts will die of the dz
Px: Favorable
Solid papillary carcinoma (SPC)
Older women (60-70 yo)
- variant of DCIS
Circumscribed, solid nodules of cancerous oval / spindly epithelial cells possibly streaming like UDH
No real papillae (inconspicuous papillae), but strands of fibrovascular network running through
- typically has a single, large, expansile mass or multiple solid, closely opposed nodules and can show spindle cells morphology and mucin production
May have neuroendocrine features ((+) chromogranin, synaptophysin)
Intra- / extracellular mucin production common
IHC: (+) ER/PR, mucin, polarization around fibrovascular (fv) core differentiate this from UDH, can show neuroendocrine differentiation and be SYN and CHR +
- neg CK5/6, MEP markers
-- also lack ME layer
Px: usually indolent, but may met (low rates of mets, staged like an in situ lesion, pTis)
- may consider invasive SPC if has geographic "jigsaw" pattern with ragged irreg borders in absence of MEP cells
- if assoc c invasive ca, assoc c mucinous ca
Invasive Papillary Ca (IPC)
Papillary nests c fv core covered in malig cells go through stroma
- rare
Often assc c other invasive ca's
- may be difficult to tell in situ papillary ca from ipc
Tx: excision
Px: Good

Intraductal papilloma (IP)

A-D. Intraductal Papilloma (IP). C is CK5. D is p63

Adenomyoepithelioma

Adenomyoepithelioma (I through L). K is CK5 and L is p63



Collagenous spherulosis


IP with LG-DCIS. F is CK5. H is ADH5 cocktail with CK8/18-pink, CK5/14-brown, and p63-brown


IP with florid UDH



Papillary DCIS
Intraductal Papillary Carcinoma. C is CK5, and D is p63



Encapsulated Papillary Carcinoma (EPC). F and H are ADH5 which is a cocktail of IHC markers that includes CK8/18-pink, CK5/14-brown, and p63-brown


Solid Papillary Carcinoma (SPC). K is CK5, L is p63



Microinvasive Carcinoma
Invasion through the basement membrane no more than 1 mm (in greatest dimension)
Size: <1 mm
- if there are several areas of invasion, the largest one counts
- fulfilling these criteria classifies the lesion as "T1mic"
Cannot be distinguished through radiology or grossly; only through micro
MC c high-grade DCIS; but can happen c any grade or LCIS
- clues for microinvasion: stromal desmoplasia, periductal lymph infiltrate, ducts c DCIS
- vascularized mucin should raise suspicion for neoplastic process
Microinvasive areas lack outer ME layer (good stains: calponin, sm myosin heavy chain, p63)
- benign or in situ lesions have positive staining for MEP markers, whereas invasive CA shows loss of MEP staining at the periphery of each glandular structure
- cytokeratins can help to show the presence of malignant cells of microinvasive ca arising in background of DCIS
EXCEPTIONS - some invasive ca express MEP markers, such as adenoid cystic ca, and metaplastic ca
- in these cases must carefully evaluate the location of MEP + cells (nonperipheral, linear location)
- benign lesions without MEP markers include MGA
Ddx: should run ER, PR, HER2 (be careful bc recut slides may be too deeply cut)
- some things are commonly mistaken as microinvasive: distortions caused by ca (lobular involvement, involved duct branches), fibrosed duct branches, crush / cautery artifact, artifact from specimen handling
Tx: axillary LN dissection
- vs DCIS (no LN dissection if limited; do the dissection if DCIS is widespread, even without evidence of microinvasion)
- axillary LNs positive for ca in up to 20% of cases
Px: same or possibly a bit worse than the grade of the original ca


Examples of immunohistochemistry (IHC) in nonbasal-like ductal carcinoma in situ (DCIS) (A and B), invasive ductal carcinoma (C and D), basal-like DCIS (E and F), adenoid cystic carcinoma (G and H), and microglandular adenosis (I through L). ADH5 is a cocktail of IHC markers that includes CK8/18-pink, CK5/14-brown, and p63-brown (hematoxylin-eosin, [A] and [C, E, G, and I]; p63, [B] and [H and K]; ADH5, [D]; CK5, [F]; estrogen receptor, [J]; S100, [L]).
Peng et al. Immunohistochemical Analysis of Breast Lesions. Arch Pathol Lab Med Vol 141 August 2017
Invasive Breast Cancer
Invasive ductal ca
MC form (70-75%) , usually presenting on mammo (spiculed c calcs) and / or palpable mass
Grossly a white, gritty, firm, stellate, rock- hard mass (from desmoplasia [without which they would be tan and soft])
Micro: may have several different patterns (nests, single file, trabeculae, necrosis)
- borders can be infiltrating, pushing, circumscribed, or a mix
-- surrounding desmoplasia and presence of DCIS is variable
Large central acellular zone is a central fibrotic region that can show some necrosis and is surrounded by a region of invasive ductal ca
- focus is assoc c central hypoxia
- has a worse px than tumors of same grande and stage
Px: mits, gland formation, nuclear pleomorphism determining factors
- poor px if has central fibrotic zone, which is more likely to met to brain
- inc in MIB-1 labelling may be assoc c inc risk of mets
Dx: ER (80%), PR, HER2 (15%) variable, E-cadherin should be positive (membranous; can be faint)
- mandatory to measure ER/PR in all invasive ca's
- ER/PR have no prognostic implications, but rather predict response to therapy (ie tamoxifen)
-- HER2 inversely related to ER/PR (and negative in tubular, mucinous and medullary carcinomas)
Dx of exclusion
Invasive lobular ca
2nd MCC invasive breast ca (5-15% of total)
- recent increase may be related use of HRT
commonly are multifocal unilaterally or bilateral (up to 50%)
LCIS co-exists c invasive lobular in up to 80%
- presents similarly to invasive ductal
Gross: like invasive ductal, but can be more rubbery
Micro: Classically invade as loosely cohesive (E-cadherin negative [85%]), from 16q22.1 loss) cells in single-file (Indian file) lines, circling ducts
- nuclei are uniform and eccentric (rarely appear as signet rings [there is a signet ring form]), possibly with reddish cytoplasmic inclusion
IHC: (+) HMWK, ER/PR, mucicarmine
- negative E-cadherin, HER2
-- usually Luminal A
Solid form
Invading tumor cells grow in sheets and there is little stroma between cells
Alveolar form
Groups of 20+ cells separated by thin stroma
Trabecular form (similar to classical form)
Pleomorphic form
Invade similar to classic form, but cells are larger and have greater nuclear pleomorphism
- frequently shows apocrine differentiation, signet-ring morphology, and nuclear pleomorphism
Histiocytoid carcinoma
Cells fave foamy, pale-red cytoplasm with a little bit of nuclear pleomorphism
- (+) Gross Cystic Disease Fluid Protein (GCDFP): indicative of apocrine differentiation
DDx: Have higher rates of ER/PR (+) than invasive ductal NOS, usually HER2 negative
- pleomorphic form ER/PR negative
- (+) E-cadherin does not necessarily exclude
- most are Luminal A (thus are not receptive to chemo [ie no need to send for genetic testing]), though sometimes luminal B, HER2, or basal-like groups
- typically B-Catenin negative (vs (+) B-catenin in invasive ductal)
- p120 (+) in cytoplasm (vs invasive ductal, which is p120 (+) in membrane [mostly]), and indicates loss of function of E-cadherin if pos
-- p120 catenin anchors E-cadherin complex to actin cytoskeletal fibers, cr band 11q11, normal ductal p120 is membranous, identical to e-cadherin in normal staining, but accumulates in cytoplasmic with e-cadherin loss
~4-5% of invasive lobular cancers are HER2+
Beaded focal segmental staining with E-cadherin is aberrant staining
Px: Similar to invasive ductal
- classical form may be slightly better and signet-ring predominant form may be slightly worse
-- signet ring form commonly presents c mets to the genital and gastrointestinal tracts and must be ddx'd from adenoca arising from other organs
- mets to leptomeninges (MCC carcinomatous meningitis), peritoneal surface, GI, reproductive organs and bone
DDx: may cause desmoplasia, but can be mistaken for foamy macrophages
- pleomorphic form may be esp hard to dx
- look for intracytoplasmic vacuoles (if present will be (+) mucicarmine) and use immunos if necessary
CK stains on LNs can reduce false negative rate
5% of lesions have both ductal and lobular features
- if margins are positive and tumor is E-cadherin negative (invasive lobular carcinoma) surgeon will NOT go back back to resect, if tumor is E-cadherin positive (invasive ductal ca) surgeon will go back and get new margins
Tubulolobular carcinoma has both
- prob derived from ductal ca bc (+) E-cadherin
Tubular carcinoma
Infiltrative but with low mets (15%), excellent prog
- up to 27% of breast ca's
***remember Rosen triad (of TLC): Tubular Carcinoma (TC); Lobular Carcinoma in situ (LCIS), Columnar cell lesion (CCL)
Grossly indistinguishable from ductal ca.
Micro: scattered oval glands c single-layer epithelium (no ME cells) with angulated (teardrop) dilated infiltrative tubules hat radiate outward and have snouts
- usually surrounded by desmoplasia
IHC: Usually ER/PR (+), HER2 negative (thus Luminal A), (+) ER/PR, EMA
- neg S100
- should have dropout of p63 and SMM (negative)
- are Luminal A
- assoc c Flat Epithelial Atypia
DDx: sclerosing adenosis, radial scars, microglandular adenosis (also does not have ME layer), tubular adenosis (may need immuno's)
Px: Relatively good
- rarely has mets to LN (in 1/10)
Invasive cribriform carcinoma
Uncommon (up to 3%)
Grossly spiculated cells, 1/5 are multifocal
Cells fairly uniform, form fenestrated islands
Assoc c tubular ca (up to 20%)
- also DCIS (up to 80%)
ER(+; almost 100%), PR(+, in 66%), HER2 negative
- are Luminal A
DDx: Cribriform DCIS (maintains architecture of ducts and lobes vs invasive cribriform); adenoid cystic ca (have ME cells and BM, and are ER negative
Px: Favorable
Mucinous carcinoma
aka colloid carcinoma
2% of invasive ca
occurs over wider age range, usually presenting with lesion on mammo (well-circumscribed, lobulated)
Extracellular mucin production with clumps of tumor cells swimming in them
- tumor cells can have complex architecture but should be low to intermediate grade
Type A - low cellularity
Type B - high cellularity
- usually have endocrine differentiation (cytoplasmic argyrophilic granules or (+) chromogranin / synaptophysin)
Are ER (+), PR (+, 70%), no HER2 amplification, no genomic instability
- stong MUC2+, decreased MUC1
- mucin can be acid or neutral type
- usually luminal A
Px: Favorable; ~ 12% axillary LN mets (usually if >1 cm, worst prognostic factor)
- may have late recurrence
DDx: Mucocele-like lesions (cystically dilated, mucin-filled ducts, assoc c mucin busting out into stroma)
- cyst epithelium may break free and float in mucin pools, mimicking mucinous ca (may be impossible to differentiate on bx, must excise), but thus usually more linear
also mucinous cystadenocarcinma
Medullary carcinoma
aka carcinoma c medullary features
Rare (<1%)
Usually younger women (~50 yo[?]) c palpable mass, usually well-defined c BRCA1 mutation
- lots of lymphoplasmacytic infiltrate, microscopic circumscription, grade 2-3 nuclei and numerous mits, no glandular differentiation, little stroma, >75% syncytial growth pattern
- no / little assoc c DCIS
Triple negative (ER/PR/HER2)
- variable CK5/6, 14, 15, EGFR
- lots of genomic instability
-- medullary features assoc c BRCA1 mutations
-- p53 mutations very common (up to 90%+)
- in basal-like group (triple negative)
Px: excellent, but low if >3 axLN mets
- may have better px than other invasive ca's; death usually occurs in 5 yrs
DDx: Lymphoma (large ca cells, little stroma, admixed lymph and plasma cells) - important to get IHCs
- Mets to LN: lacks LN architecture
Invasive micropapillary ca
< 2% invasive ca; although a lot of tumors will have micropapillary features, can only diagnose this if there are >90% micropapillary structures
- MC to see assoc c invasive ductal NST
No distinguishable presenting, mammo, or gross characteristics
These lack fibrovascular cores (vs real papillary lesions)
- have "inside-out" polarity of cells, visible c EMA (+) on outside edges
MC assoc c DCIS c micropapillary / mucinous features
ER (+, up to 100%), PR variable (50%), has a higher chance of being HER2+
- usually luminal A or B
DDx: can be difficult to differentiate from LVI
- may mimic serous papillary ca of ovary
- invasive ductal ca has EMA on cell's inner surface
- must consider mets from ovary, lung, or bladder, which can also have micropapillary pattern
Px: usually have axLN mets (>4 aLN mets at the time of presentation) and poor px (~1/2 recur), similar to invasive ca NST
- up to 67% c LVI, 75% c axLN mets
Metaplastic carcinoma
2 basic types are pure epithelial ca and mixed epithelial and mesenchymal ca 2-5% of ductal ca
- should be at the top of the ddx of a spindle cell breast lesion
- high grade lesions c spindle cells, keloid-like collagen matrix, without a component of atypical ductal hyperplasia or DCIS
heterogenous group of ca with metaplasia to nonglandular (ie squamous) or mesenchymal (ie spindly, chondroid, osseous or myoid) cell type
- uncommon, <1%, usually perimenopausal women, grows rapidly
No specific presenting / gross features, though may detect ossification
Heterogenous on micro, with possible aforementioned features
- spindle cells assoc c squamous differentiation
- Bone and cartilage are MC mesenchymal types
-- must include phyllodes tumor and pure sarcoma in ddx if bone / cartilage present
MNF116, 34βE12, and CK5/6 may be necessary for proper dx
- can be complicated by (+) focal stains in phyllodes tumor
Adenoquamous ca usually smaller than other subtypes (~2.5 cm)
- usually arise in sclerosing lesion, with well-formed squished glands and solid cords in strange infiltrating pattern
- look for thick stroma with lymph infiltrate around ca cells
- can use p64, sm myosin, CD10 and calponin to see ME cells around tumor cells, usually in lamellar pattern
-- cytokeratins stain stronger in luminal than basal epithelial cells characteristically
Most are triple negative (basal-like) and have TP53 mutations
- CK 903, 7, 5/6, 14, 17, CAM5.2, EGFR, p63 focally expressed, OSCAR has been found to be + in ~91% (may be better than HMWK)
- can be difficult to differentiate from myoepithelial carcinomas from sm actin
- may also fit the new claudin-low subtype
DDx: fibroepithelial tumors, myofibroblastic tumor, myofibroblastoma, fibromatosis, chondroblastic osteosarcoma (negative GATA3, p63 and keratin staining)
Px: difficult to assess and variable, but depends on size
- mets to lung and brain w/o axLN mets
- usually respond less to conventional chemo, worse outcome than other triple negative tumors
Adenoid cystic carcinoma
< 1% of invasive ca's c variable, non-specific clinical, gross presentation
Micro: Similar to adenoid cystic ca from salivary glands
- have red BM material present, variable glandular, squamous and sebaceous differentiation
- can have true (surrounded by CK-7 (+) epithelial cells c red cytoplasm) and pseudo-lumens ( c myxoid or red spherules made of BM [type IV collagen and laminin], surrounded by ME cells c little cytoplasm)
IHC: Usually triple negative
- (+) CD117 (not specific), CK5/6, CK903, and P63 (+)
- thus you must be careful because these lesions express MEP markers even though it is an invasive ca!!!
- salivary gland and breast type have t(6:9)(q22-23;p23-24) causing MYB-NFIB fusion gene
DDx: may develop c invasive cribriform ca ([+ ER/PR], no ME layer, no intraluminal BM material) or collagenous spherulosis (not infiltrative)
Px: excellent; rare axLN mets or mets in general
- can develop c microglandular adenosis, LVI, perineural invasion, DCIS
Ca c NE features
Shows morphologic and IHC NE features, and may secrete hormones
- generally presents like other ca's
Can be seen in 30% of non-specific invasive ca's, but also c mucinous and solid papillary ca's
DDx: may be indistinguishable from met of NE to breast (< 1% of breast ca's), or met of small cell or large cell NE ca - can look for nearby DCIS to help differentiate
- E-cadherin, chromogranin, and synaptophysin may help
-- may need clinical correlation to r/o other primary site
IHC: Usually ER/PR (+), HER2 negative
- usually luminal A
Mets to axLN same as invasive ductal ca of NST
Ca c apocrine differentiation
<1 % show pure apocrine features, though most ca's have some apocrine differentiation
- No distinct presenting features
Micro:Cells have abundant, foamy, red cytoplasm, round nuclei c prominent nucleoli
IHC: ER/PR negative, androgen receptor / GCDFP (+), HER2 variable ( 50%)
Genes: 50% have distinct gene expression profile, the rest are luminal and HER2 molecular subtypes
DDx: may look like infiltrating histiocytes or granular cell tumor - get IHC to differentiate
Px: similar to invasive ductal ca
Inflammatory carcinoma
Locally advanced (high-grade) ca c characteristic peau d'orange, inflamed clinical appearance
- caused by tumor cells invasion in dermal lymphvascular spaces obstructing flow
-- though no lymph infiltrate into stroma predominantly
- skin bx will not necessarily show ca cells from sampling error
- can be due to ca recurrence
IHC: ER/PR variable (50%), HER2 variable (40%)
Px: used to be very poor, now better due to neoadjuvant and radiation tx
Is a clinical dx c pathologic correlate
Invasive ca c Osteoclast-like GCs
Appear as histiocytes on IHC and EM
Similar presentation as other invasive ca's
- may grossly be brown due to hemorrhage
Px: similar to invasive ca's
Lipid / glycogen-rich ca
These substances abound in the ca cells, more than normal amt
- vacuolated, clear cytoplasm
Not really a distinct entity
Pleomorphic ca
High-grade invasive ca c >50% cells c marked pleomorphism and inc mits
ER/PR negative
Prognosis poor, but similar to other high-grade invasive ca's
Invasive ca c choriocarcinomatous features
Very rare, assoc c other invasive ca's (only 2 described cases)
Produces hCG
Should consider breast mets
Hereditary Breast Ca
Up to 10% breast ca caused by high-penetrance genes
- BRCA1 and 2 best characterized; esp prevalent in Ashkenazi Jews
- AD, high penetrance, 80% lifetime risk of breast ca (vs 10% in general population), c additional inc risk of neoplasms of ovary, fallopian tube, colon, uterus and pancreas
- inc risk of prostate ca in males
- ~5% of all women c breast ca and 25% of Ashkenazi Jewish women c breast cancer have a germline BRCA mutation
- in a woman c breast ca who is found to harbor a BRCA mutation, the risk of cancer developing in the contralateral breast is 25%
BRCA1 [17q21] tumor suppressor gene assoc c high-grade, high mits, solid cell sheets, lymph infiltrate, necrosis, pushing border
- are more often triple negative, and are basal-like by IHC
- Ca c medullary features more common c BRCA1
No clear morphologic assoc c BRCA2 [13q12-13]
USPSTF recommends women whose fam hx assoc c inc risk for deleterious muts in BRCA1 or BRCA2 genes be referred for genetic counseling and BRCA testing (B recommendation)
USPSTF recommends against routine genetic counseling or BRCA testing for women whose fam hx not assoc c inc risk for potenitally harmful muts in BRCA1/2 genes (D recommendation)
BRCA TESTING NOT GIVEN TO ALL WOMEN BC:
- waste of resources; mngment vars of uncertain clin sig; poss for unnec worry on part of pts and fams; potential for genetic discrimination
One study of 972 women found 92 BRCA vars, most c unclear pathogenicity
- pretest probability is crucial
- there are risk scring programs (BRCAPRO, Gail, Tyrer-Cuzick, Claus)
Single most important px factor is axLN status
Can group into macro- or micrometastases or isolated tumor cells
- macromets obviously worst px, but micro and ITCs less clear px (statistically but not clinically important)
Tumor size (after axLN) next important px factor
- can be grossly or microscopically determined
-- AJCC states that should measure only the invasive component
- may be problematic due to tumor bx removal
Tubular, mucinous, invasive cribriform, and adenoid cystic ca's have excellent prognoses
Tumor grade by Nottingham system also important
- uses tubules (10 and 75% cutoffs), nuclear grade (Low, Med, High), and Mits (5 and 10 cutoffs) to score from 1-3
-- Scoring: Grade 1: 3-5; Grade 2:6-7; Grade 3: 8-9
- most helpful in conjunction c lobular and mucinous ca's
- high histo grade has better chemo response
Nottingham Prognostic Index stratifies into good, moderate and poor px (c 3, 7, and 30% respective mortalities) based on tumor size, axLN status, and grade
LVI important in predicting axLN / distant mets
- usually goes into lymph, not vessels
- should be assessed in peritumoral tissue; should not take the shape of the vessel (suggests artifact)
- D2-40 ab to podoplatin good to assess LVI bc highlights lymph endothelial cells
ER/PR status best correlates c response to hormonal tx, but is poor px indicator
- should be done on all invasive ca's
- must be >1% to be considered (+)
Similarly, HER2 assessed to check for potential use of trastuzumab (Herceptin) and lapatinib (Tykerb)
- (+) if >30%
- for FISH, (+) if HER2/ CEP17 (centromere enumeration probe 17) > 2.2 or >6 HER2 signals / cell
Proliferative rate (through Ki67) and extent of DCIS can be significantly prognostic
- blood vessel invasion, mononuclear inflam cell infiltrate, and perineural invasion of unclear prognostic importance
In early stage, ER-(+) HER2 neg pts, OncotypeDX may predict tx response using 21 gene rtPCR
- calculates a recurrence score from 0-100
-- a high score (>31) has 30% distant relapse probability in 10 years
- mixed training and testing data during validation = no no???, results may not be reliable, see High False Negative Rate paper by Dabbs (there was an FDA bulletin from 2014 or 2015)
MammaPrint uses 70 gene assay to predict px
- used on node-negative tumors <5 cm that are independent of ER status
- should be used if there is clinically high risk of recurrence, does not really matter what the genomic risk of recurrence is
Can calculate the recurrence score based on the Magee equation
-
TAILORx trial - do not need to give chemo for intermediate scores
Molecular classification of Breast Ca
Types: Luminal A, Luminal B, HER2, and basal-like
- not necessary now to classify, but doing IHCs still help c tx
Luminal tumors called so bc of high expression of genes normally in breast luminal epithelium, and ER/PR genes (LIV1, GATA3, HNF3A and X-box binding protein 1)
- there is a Luminal C which has genes of unknown significance (GGH, LAPTMB4, NSEP1, CCNE1)
Luminal A
ER and/or PR (+), HER2 negative, Ki67 < 14%; CK8/18+
- low grade ductal NOS, good px; little benefit of giving chemotx
Luminal B
ER and / or PR (+), HER2 negative, Ki67 >14%
or
ER and / or PR (+) and HER2 (+) (luminal HER2)
- also CK8/18+
- higher grade than luminal A (thus worse px); ER/PR is (+) but less so than in luminal A
- luminals will respond to hormone therapy, have variable chemo response, and a generally favorable px
- may use PHP3 for proliferative index (?)
- tumors generally will not transform from low to high grade, but luminal B type is an exception (50% do!)
HER2
ER / PR negative, HER2 (+), high Ki67
- about 15% of invasive breast ca's
- more likely to be high grade and have (+) axLN
- needs to be formalin fixed from 6 to 48 hours for testing, and have a cold-ischemia time of <1 hr
- by IHC, only circumferential membranous staining is considered
- expression reported as 0-3+, depending on the proportion of cells displaying strong circumferential membranous staining
- 0-1+ considered negative, 3+ is positive and 2+ is equivocal
By FISH, amplification determined by calculating ratio of signals from Her2 to CEP 17; amplification defined as ration >2.2; negative result is a ratio of <1.8
- equivocal FISH results (ratio bwt 1.8 and 2.2) should be repeated or more cells counted. If repeatedly equivocal FISH results obtained, consider IHC (if not already done)
- HER2/neu is an oncogene that encodes a transmembrane glycoprotein with tyrosine kinase activity known as p185 that belongs to family of epidermal growth factor receptors
Tx: respond to HER2 tx (given weekly or monthly for 1 year), and anthracycline-based chemo
-- basal tumors respond even better to chemo
Px: poor
Basal-like
So called bc expresses genes expressed by MECs (for CK 5 and 17, epidermal growth factor receptor); although probably originate from luminal progenitor cells or have some stem-cellish characteristics
- can express P-cadherin, caveolins 1 and 2, nestin, αβ crystallin and CD109
- TP53 mutated in up to 85%
- possible link to BRCA1 pathway mutations
Triple negative breast ca (TNBC), high Ki67, CK5/6 and / or EGFR (+)
- about 15% of all breast ca's
- high grade, few tubules, high mits, necrosis, solid architecture
- commonly have BRCA1 mutations
- common in blacks and younger pts
- no tx response to hormonal or HER2, are more aggressive (dec survival, mets sooner [to brain and lungs]), do not usually met to LN bone or liver (as in non-TNBC)
- also typically have lower expression of Androgen Receptors (AR)
Not all triple negative breast ca's are basal-like, and only about 3/4 cancers that are basal-like by IHC are also basal-like by genetic testing!
- basal-like TNBC have CK5, CK5/6 or EGFR positivity, have a worse px than non-basal like TNBC
- basal-like TNBC are well-circumscribed c pushing border and have central tumor necrosis, and have high Ki-67 and high p53 expression
6 molecular subtypes of TNBCs:
1) Basal-like carcinoma (BL1 and BL2); the major subtype
- may be better treated by taxanes due to high prolif index
2) Immunomodulatory
3) Mesenchymal
4) Mesenchymal stemlike
5) Luminal androgen receptor (express ARs more frequently)
- may be assoc c better px
- may be tx'd c anti-androgen therapy
6) Unstable subtypes
Metastatic TNBC usually does not express ER/PR, GCDFP-15, or mammaglobin, but CK5/6 expressed in 62.3% and EGFR in 91%
- pts c p53 overexpression have worse outcomes than those without
- there is a positive correlation bwt p16 and Ki67 in p53 neg tumors (but not p53+ tumors)
Differentiating bwt TNBC and metastatic HG-serous ca is important
- both can be ER-/PR-/HER2-/p53+/p16+ with similar morphology
-- in this case breast will be GATA3+/PAX8-/WT1- and serous ca is GATA3-/PAX8+/WT1+
- GATA3 esp useful in TNBCs where other markers usually neg, although sens in TNBC up to 66%
- PELP1 may be more sens than GATA3 in TNBCs
Possibly sensitive to platinum-based chemo and PARP inhibitors
- PARP inhibitors work bst on BRCA1 tumors by breaking double-stranded DNA and causing cell death
Px: POOR, esp in first 5 yrs; worst 5-yr survival of any breast ca
-- exceptions are adenoid cystic ca and secretory ca's of breast
Recurrence Score (RS) is a 21 gene panel that gives score from 0-100 from oncotype DX that predicts relapse free interval and overall survival and chemo response in ER+ LN - ca's
- mammaprint used for node negative invasive tumors 5 cm or less that cn be ER/PR + or neg that uses a 70 gene panel
HER2 (named so due to human epidermal growth receptor), NEU (named from rat neuro/glioblastoma cell lines), EGFR/ERBB1 (bc similar to human epidermal growth factor receptor)
- HER2 found in ~20% of breast ca., assoc c worse prognosis (has better response to anthracycline tx, but not to endocrine tx)
-- HER2 scored as 3+ when IHC >30%; 11-30% is a score of 2+ which requires FISH analysis to determine whether to tx c trastuzumab
--- Chromogenic In Situ Hybridization (CISH) uses diaminobenizidine (DAB) as the chromogen to generate brown signals and may show better morphologic detail
- HER2 assoc c apocrine differentiation
- brain mets have become more common with use of trastuzumab (not able to cross BBB)
- low RS scores avoid chemo while high scores get it
- not indicated in ER+/HER2+
Genomic Grading Index (GGI) more closely related to histologic grade than stage
- applies to ER (+) tumors
- developed by comparing grade 1 and III signatures, grade II tumors are primarily either grade I or III
Molecular apocrine
ER (-); androgen receptor (-; though is (+) based on molecular??)
- shows apocrine features on histology; are GCDFP-15 (+)
Have high prolif (Ki67) and grade
Claudin-low
Are less differentiated than basal-like cancers, are poorly differentiated and metaplastic; and have stem-cell like expression profiles;
- despite being less differentiated, have a slightly better px than basal-like; although the complete pathologic response is lower[??]
Low grade and high grade lesions most likely have different molecular pathogenesis (vs the hyperplasia of usual type [HUT] hypothesis that they stem from a common abnormality)
- low grade tumors have 1q+, 16q- whereas high grade lesions have 1q+, 3q+, 17q+, 20q+, 8q+, 5q-, 11q-, 14q-, 8p- and 13q-
-- explains Rosen's triad: columnar cell lesions, flat epithelial atypia, lobular neoplasia and tubular carcinoma usually found together
CDH1 is the e-cadherin gene, and is found commonly in low grade ductal and lobular neoplasms
Invasive ductal ca (C), with staining by ADH 5 (stains CK8/18 pink, CK5/14 brown and p63 brown)



Invasive lobular carcinoma

Pleomorphic lobular carcinoma

Histiocytoid carcinoma of breast

Tubular carcinoma


Invasive cribriform ca of breast



Mucinous carcinoma




Micropapillary ca

Metaplastic carcinoma



Adenoid cystic ca (G and H). H is p63. Be careful because this is an invasive ca that expresses MEP markers!!!
Peng et al. IHC Analysis Breast, Arch Pathol Lab Med 2017

Inflammatory carcinoma
AJCC 7th ed Breast ca staging



Spindle Cell Lesions
Considered spindle cell carcinoma until proven otherwise
- could be phylloides tumor
Spindle cell carcinoma
Uncommon (<1% of invasive breast ca's)
Micro: variable appearance (from bland [fibromatosis-like (FLSCC)] to very pleomorphic high-grade sarcomas); varable mits; borders usually infiltrative (entraps lobes and ducts)
- can obliterate normal architecture, appear vascular, or epithelioid
-- bone / cartilage may be present
- may assoc c DCIS
-- should get IHC panel to confirm: MNF116 (broad-spectrum CK) and 34βE12 or CK5/6 (HMW/basal CK) to detect epithelial cells
(+) p63, vimentin, SM actin, and muscle-specific actin usually positive
- typically triple negative; categorized as basal-like or claudin low
Low-grade Fibromatosis-Like (metaplastic) Spindle-Cell Carcinoma (FLSCC)
Made of almost entirely bland spindle cells, like fibromatosis
- Have irregular borders that seem to infiltrate into normal breast parenchyma / glands, but can sometimes appear well-encapsulated
-- may have small epithelial component, revealing metaplastic nature of the disease
Small cohesive clusters of fusiform to polygonal epithelioid cells c rounded nuclei and prominent nucleoli scattered amongst spindle cells is a defining feature1
- may not see these exact cells, but a metaplastic variant bwt squames and these
IHC: spindle cell part has (+) basal cytokeratins and vimentin but (-) luminal cytokeratins, smooth muscle myosin heavy chain, epithelial membrane antigen (suggests metaplastic squamous epithelium)
- (+) nuclear p63 points to myoepithelial origin, is (+) in >90% of these tumors
- epithelioid part (+) all CKs, epithelial membrane antigen
(-) vimentin
Tx for FLSCC: simple excision (no chemorads)
Px: Rarely metastasize, but like to recur locally
- similar to pure fibromatosis
1. Dwyer, Jessica. Low-Grade Fibromatosis-like SPindle Cell Carcinoma of the Breast. Arch Pathol Lab Med. April 2015; 139: 552-557.
Low-grade fibromatosis-like metaplastic breast carcinoma

Fibromatosis
Assoc c Familial Adenomatous Polyposis and Gardner syndrome but otherwise occurs in pts in their 20-40's
Presents as painless, slow-growing mass
Firm mass with fibroblasts and myofibroblasts that is infiltrative and aggressive but does not met; entraps ducts and lobes
- likes to recur locally (up to 30%; need wide margins)
Micro: Long fascicles of uniform, bland spindle cells (fibroblasts) c pale, reddish cytoplasm and unclear cell borders
- traps benign breast glands and lymphs
- usually more cellular at periphery of lesion than at its center (lymphoid follicle usually seen at periphery of lesion)
-- little or no mits
- has similar histo as desmoid tumor
IHC: (+) SMA, actin; in a few cells will have (+) S100 and desmin; (+) β-catenin in 75% (non-specific; also in phyllodes tumor)
- neg: nuclear B-catenin, p63, keratins, CK903, CD34, ER
DDx: scar (will have hemosiderin, fat necrosis, histiocytes, and FBGCs), fascicular PASH (has a space adjacent to the cells), and fibromatosis-like metaplastic carcinoma (will have areas of epithelioid-appearance and (+) CK and p63 in spindle cells)
Px: high recurrence rate, esp if not excised c wide margins
Fibromatosis, breast

Inflammatory myofibroblastic tumor
- aka inflammatory pseudotumor
May occur in breast, but usually is peripheral
Micro: mix of fibroblasts and myofibroblasts with any mix of leukos in myxoid to collagenized stroma
IHC: spindle cells (+) vimentin, smooth muscle actin, factor XIIIa, sometimes desmin, cytokeratin, anaplastic lymphoma kinase
MTMF


Epithelioid MF

MTMF

Mammary-type Myofibroblastoma (MTMF)
Uncommon; equally in men and women, older
- slow-growing, lobular, well-circumscribed, can occur anywhere in body; usually subQ, but can be intramuscular
- May be interpreted as fibroadenoma clinically and on mammo
- whorled and rubbery c yellow or gray cut surface
Is not truly encapsulated (can be well circumscribed)
Several types: Infiltrative, celular, myxoid, collagenized, deciduoid, lipomatous, atypical and epithelioid
- epithelioid type can be confused c invasive lobular carcinoma, except MTMF has pushing border, prominent collagen bundles, no entrapped glands, low mits and no atypical mits or necrosis
Micro: Short fascicles of uniform, bland spindly cells c round nuclei bwt hyalinized collagen bands c short, stubby nuclei
- has variable fat, low mets, no necrosis or cysts
- commonly see lymphoid infiltrates and mast cells (chronic inflam)
- can see cartilage, bone, muscle, rarely a neurilemmoma-like pattern
IHC: spindle cells (+) CD34, vimentin, desmin, ER, PR, androgen receptors
- variable (muscle-specific and smooth muscle) actin, bcl-2, CD99
- Negative: EMA, CD31, CKs, S100, smooth muscle myosin heavy chain and HMB45, keratin, MDM2, B-catenin
DDx: Spindle cell sarcoma / carcinoma (will have CKs and EMA +)
- other carcinomas (esp invasive lobular [can look like epithelioid type])
- reactive lesions (spindle cell lipoma, solitary fibrous tumor, nodular fasciitis, smooth muscle tumors, fascicular pseudoangiomatous stromal hyperplasia)
Genes: 13q14 c aberrations of RB1 (shared c spindle cell lipoma and cellular angiofibroma)
Nodular fasciitis
Presents as rapidly growing mass; mimics a malignant tumor
- usually occurs in the extremities, but may occur in breast
- will spontaneously regress
May be highly cellular, but is variable
Micro: Big fat spindle myofibroblasts with big, uniform nucleoli growing in small fascicles and whorls
- can have lots of mits
- benign glands do not get trapped (vs fibromatosis)
IHC: spindle cells (+) vimentin, smooth muscle actin (SMA), muscle-specific actin
(-) CKs, desmin, ER, nuclear B-catenin, CD34
DDx: spindle cell carcinoma / sarcoma; fibromatosis
Spindle cell sarcoma
- usually the stromal component of phyllodes tumor
- angiosarcoma is the MCC sarcoma in breast
Vascular lesions
Benign lesions are rare and must be differentiated from angiosarcoma (has interanastomosing channels, atypia, and endothelial proliferation)
- must see entire lesion (not possible on bx or partial excision)
Perilobular hemangiomas
MC breast vascular lesion
- in up to 11% of all breasts
Basically very small capillary hemangiomas
- circumscribed, thin-walled ectatic vessels lined by flat epithelium
- can be anywhere in the stroma
- may have some small degree of atypia
Hemangiomas
- big enough to be seen on mammo or clinically
Types:
cavernous: dilated vessels full of RBCs
capillary: compact, small vessels that can resemble a pyogenic granuloma
complex: mix of cavernous and capillary
Can be thrombosed or have papillary endothelial hyperplasia, similar to angiosarcoma
- atypical hemangiomas can have focal atypia
Venous hemangioma
Rare; vascular structures with varying thick walls
Angiomatosis
- aka diffuse hemangioma
Rare; dilated anastamosing contiguous vessels seen in first 2 decades of life
- capillary-sized vessels, cavernous and venous channels
- no atypia
Not circumscribed and may involve large areas of the breast
- b9
Tx: excision; has a high recurrence rate

Angiosarcoma
MC primary sarcoma of breast
- uncommon ( < 1% of breast malignancies)
May be primary or secondary (tx effects [post-rad])
- primary lesions occur in younger pts; though the higher the grade of a primary lesion, the younger the pt and worse px
Stewart-Treves syndrome: angiosarcoma arising in arm from chronic lymphedema
Clinically can appear blue or violaceous
Grossly are hemorrhagic masses of varying sizes
Micro: interanastomosing vascular spaces that go through stroma and adipose and disrupt normal architecture
- high and intermediate grade lesions have higher cellularity and higher mit rates
Can be low, intermediate or high grade depending on histologic features, and different grades are often found on single lesion so good sampling is very important!
- endothelial tufting, papillary formations, solid and spindle cell foci, mits, blood lakes, necrosis
- Low grade lesions can be esp hard to spot, and foci of high-grade lesions can exist amongst a low-grade lesion
Tx: mastectomy
- axLN mets rare; MC to go to lung, liver, other breast, or bone
Px: poor (<3 yrs), esp in younger pts; older pts tend to have lower grade lesions and better px
DDx: benign vascular lesions (ie papillary endothelial hyperplasia [aka Masson vegetant intravascular hemangioendothelioma], which is primarily intravascular)
- Ki67 may help in dx from hemangiomas
- to dx from carcinoma, should get F VIII-related antigen, CD31/34, and D2-40
Atypical vascular lesion (AVL)
- aka benign lymphangiomatous papules of the skin
Small papules / plaques c pink to brown discoloration which occur a couple years after radiation and can be confused c angiosarcoma
Dilated and sometimes anastamosing vascular channels that are circumscribed and can have dilated lymph spaces that are assoc c lymph follicles
- no mits, no prominent nucleoli
Usually c chronic inflam infiltrate
May divide into lymphatic (MC) and vascular types
Vascular type looks like capillary hemangioma but can have some atypia and will have a lobulocentric configuration
Negative for MYC amplification versus positive in angiosarcoma - may not be enough to differentiate benign vascular lesions from angiosarcoma
AVL is negative for c-MYC
Px: Benign; tend to recur


Benign Lymphangiomatous Papules
Papillary Endothelial Hyperplasia
- aka Masson vegetant intravascular hemangioendothelioma
Circumscribed, intravascular, thrombi, papillary appearing, bland-looking
- most likely derived from some abnormal thrombus

Masson vegetant intravascular hemangioendothelioma
Pseudoangiomatous Stromal Hyperplasia (PASH)
Benign fibroblastic prolif. that looks like a vascular lesion
- may be found in up to 1/4 breast specimens
- assoc c phyllodes tumor, fibroadenoma, and gynecomastia
Grossly will not see the slit-like spaces (characteristic of fibroadenoma)
Micro: slit-like spaces in dense collagenous stroma with myofibroblasts at the edge of the lesion
- artefactual clefts simulate vascular channels
- can see MNGCs and some atypia and mits; uncertain significance
- breast carcinoma cells may grow along the slit-like spaces!!
IHC
(+) vimentin, CD34 (sometimes[?]); PR
- variably SM actin / desmin
- negative ER, CD31, FVIII-related antigen, Ulex europaeus
Tx: local excision
Px: do not have inc risk breast ca
1st described Human Pathology; 1985...



Other Mesenchymal Lesions
Lipoma
Present clinically and on mammo as circumscribed soft tissue mass
- difficult to dx bc fat is normal tissue in breast
Angiolipomas
Fatty tumor with fibrin thrombi within small blood vessels
"Cellular angiolipomas" have spindle cells, collapsed vessels and only a little bit of fat
"Adenolipomas" are glandular proliferations within lipomatous tumor
- may be more appropriate to call it a hamartoma
Most fatty tumors are from subQ tissue and really not the breast parenchyma
Granular cell tumor
Will mimic carcinoma clinically, on mammo and grossly
- invasive
Occur in upper inner quadrant, may be caused by hormonal factors
Grossly is gray-white, gritty, poorly circumscribed
Micro: Cytoplasmic granularity
- on EM, granules are secondary lysosomes
DDx: fat necrosis, duct ectasia (any lesion c histiocyte prolif), infiltrative carcinoma with apocrine features
(+) S100
negative cytokeratin, ER, PR
Px: benign
- derived from neuro tissue, not muscle
Tx: excision is sufficient
Myxoma
Assoc c Carney syndrome
Well-circumscribed, glistening on sectioning
Micro: hypocellular myxoid stroma with scattered spindle cells
DDx: mucinous ca, mucocele-like lesion, fibroadenoma c myxoid stroma, myxoid variant of nodular fasciitis, mets
- r/o ca c cytokeratin and p63
Inflammatory Myofibroblastic tumor
Firm, circumscribed c gray-white to yellow surface
Micro: bland myofibroblasts in interlacing fascicles and lymph infiltrate
(+) sm actin,
negative cytokeratin
DDx: spindle cell carcinoma
Px: may recur if not completely excised
Periductal stromal sarcoma
- is perductal stromal hyperplasia if mits <3/10 hpf
Usually breast mass in peri-/postmenopause
Multinodular stromal prolif around ducts/lobules with pericanalicular growth pattern
Have stromal spindle cells and benign epithelial component
- lacks the organization of phyllodes tumor
Tx: excision c clear borders
Primary breast sarcoma
- very rare; may come from chest wall
MCC is angiosarcoma, then liposarcoma
- can have any kind of sarcoma present
DDx: metaplastic carcinoma, phyllodes tumor
Granular cell tumor

Miscellaneous Rare Lesions
Amyloid tumor
pt will have an underlying systemic condition
Clinically firm, gray to white and shiny surface
Micro: red, homogenous amyloid deposition in vessel wall
- can be calcified
Wegener granulmatosis
tender mass that can mimic inflam ca
Micro: necrotizing vasculitis; granuloma at the periphery of infarcted regions
DDx: inflam, granulomas
Lymphoma
Can be primary or secondary
- primary is very rare
Grossly tan-white, may have areas of hemorrhage
- MCC DLBCL
Must differentiate large cell lymphoma from poorly differentiated carcinomas
In women c breast implants, watch out for breast implant-assoc Anaplastic Large Cell Carcinoma (BIA-ALCL)
- CD30+ and T cell phenotype
- occurs ~8 yrs after implants; not assoc c specific implant material
- made of T-cells; ALK- negative
- Tx: implant removal
Rosai-Dorfman dz
Presentation mimics carcinoma
Micro: poorly defined, multinodular aggregates of large histiocytes c polymorphous background of mature lymphos and plasma cells
- histiocytes eat the lymphos
DDx: granulomatous mastitis
Px: Indolent course
BIA-ALCL

Nipple disorders
Accessory Nipples
May be found along milk line; from axilla to groin
- histologically may have normal nipple components
Squamous Metaplasia of Lactiferous Ducts (SMOLD)
Keratin may accumulate if nipple invagination is deeper than 1-2 mm
- causes obstruction similar to epidermal inclusion cyst, which causes inflammation and possibly infection if erupts
- look for squamous metaplasia c keratin within stromal inflammatory cells to ddx from cysts
Assoc c cigarrettes; can occur at any age
Tx: Excision of ducts
- drainage and abx not effective
Px: recurrence if not completely excised
Nipple adenoma (aka florid papillomatosis of nipple, erosive adenomatosis)
Clinically looks like Paget's, c soreness and ulceration
- b9 epithelial prolif coming from subareolar ducts
Micro: well circumscribed, benign glands in fibrous stroma with varying papillomas and possibly ductal hyperplasia
- these benign glands are surrounded by ME layer
- 4 variants: sclerosing papillomatosis, papiiloma, adenosis and mixed proliferative
DDx:Paget disease, tubular carcinoma (get stain for ME cell layer)
Tx: Excision
Px: Recurs if not completely excised

nipple adenoma
Syringomatous adenoma
Broad presentation and age range; benign
- due to superficial location and infiltration in dense tissue, often evades detection radiographically
Micro: small, infiltrating glands or tubules that characteristically appear comma-shaped, small islands/cord of cells, squamous nests/cysts, fibrous/collagenous stroma c myxoid/hyaline change
- glands are angulated/teardrop-like / comma-shaped
Invades bwt lactiferous ducts and SM bundles
- lymphocytes usually infiltrate within the lesion
- can see perineural invasion
Has no ME cell layer on HE, can only see c IHCs
DDx: low-grade adenosquamous ca (arises peripherally in breast parenchyma [syringomatous adenoma is very close to nipple], low-grade adenosquamous ca may have a higher rate of local recurrence but does not met); Tubular ca (has DCIS); florid papillomatosis of nipple (has intraductal epithelial prolif)
IHC: (+) p63, esp in peripheral cells (typically retains myoepithelial markers)
Tx: excision (possibly of entire nipple)
Px: Benign; but recurs if not completely excised
- does not met


Paget's disease
In up to 4% of pts c breast ca
Presents as red, crusty, weeping lesion
Micro: epidermis infiltrated by single/groups of cells c large nuclei and nucleoli, light cytoplasm c mucin possible in lacuna (caused by shrinkage effect)
- can form tubular structures
- may be very few or can replace lots of keratinocytes
- may show cytocrinia (where tumor cells ingest melanin from neighboring melanocytes)
IHC: (+) CK7 (LMWCKs), AE1/AE3, CAM 5.2, EMA, HER2, CEA, ER, PR, androgen receptor, gross cystic disease fluid protein (GCDFP), S100, mucin (mucicarmine)
- negative CK20, HMWCK (CK903), melanoma markers
Vast majority have underlying DCIS +/- invasive ca
DDx: melanoma, Bowen dz, clear keratinocytes, Toker cells (bland, lack nucleoli, may be the origin of Paget's cells)
- mucin stain may help distinguish
Tx: if dz limited, can do breast-conservative surgery
Paget disease

Male Breast Lesions
Overview
The breast tissue of a dude has fibroadipose tissue as well as branching ducts and terminal ductules, but little (if any) acini
- lobules can be seen with high estrogen levels and Kleinfelter's syndrome in men
Other than gynecomastia, other benign lesions in male breast are possible, which look like they do in the female breast
- ie phyllodes tumor, fibroadenoma, intraductal papilloma, duct ectasia, cavernous hemangioma, pseudoangiomatous stromal hyperplasia, and myofibroblastoma
Gynecomastia
MC male breast lesion
- seen in endocrine and genetic problems and assoc c digitalis, spironolactone, TCAs, cannabis, and topical lavander and tea tree oils
Occurs during puberty and around old age (bimodal age distribution)
- 3 stages: early florid, intermediate, and late fibrotic stages
Can be localized, generalized, uni- or bilateral
Very common in newborns due to high maternal estrogens
Inc # ducts and ductal dilation
Surrounding stroma is loose early on, and may have epithelial tufting into dilated ducts, like in benign epithelial hyperplasia and some mixed chronic inflam
- epithelial hyperplasia early on (with cribriform, solid or papillary patterns) may look poor and lead to ADH or DCIS diagnosis
-- threshold for dx'ing ADH or DCIS should be high; don't really have too much info on their significance
- squamous metaplasia MC early on
In late stage the stroma becomes fibrosed and hyalinized and the epithelium atrophies
- PASH can be seen at any time
Can see lobules that have changes that look like they are about to lactate
Px: No inc risk of breast ca
Breast cancer in males
0.6% of all breast cancers
May be in situ or invasive
Occur in older pts (older than female counterpart) [50's]
Gynecomastia is not a risk factor, but Kleinfelters, hyperestrogenism (liver dz, obesity, antiandrogen tx, transexuals taking hormones), (+) FamHx (inc 20%; BRCA2, PTEN, and CHEK2 mutations), testicular injury, and exposure to high temperatures over long periods of time is
DCIS occurs right next to nipple and presents c discharge
- papillary form is MC
Invasive ca usually higher grade than those found in women
- often ER/PR (+) [more so than female breast ca's]
MC subtype is invasive ductal, followed by invasive papillary
-- appear same as those found in women, though is usually diagnosed at a more advanced stage
Px: Same as in female breast ca when corrected for stage
Mets in male breast similar as in female breast
- MC are RCC, melanoma and lymphoma
-- sometimes prostate mets here too
Breast Pathology in Children and Adolescents
Ducts without alveolar differentiation (few lobules) until puberty
- can see extramedullary hematopoiesis in breast stroma until 4 mo age
Estrogen in pubescent female causes stromal fat deposition, enlarging the breast disc
Acini grow with cyclical progesterone stim
May see fibroadenomas, phylloides tumors, and intraductal papillomas in this youngin population (histologically similar to adults)
Juvenile (Virginal) Hypertrophy
Uni- or bilateral rapid breast enlargement
Micro: similar to gynecomastia, has no lobule formation
Tx: reduction mammoplasty (as many times as necessary)
Juvenile fibroadenoma
Similar to those seen in adults
Juvenile papillomatosis
Pts <30 yo (up to 48 yo [?])
Clinically a discrete mass that may be mistaken for fibroadenoma
- no clear assoc c breast ca risk, though most have a (+) FamHx
Grossly appears as Swiss-cheese
Micro: cysts and ectatic ducts with inspissated secretions, foamy histiocytes in lumen, apocrine metaplasia, epithelial papillomatosis and hypertrophy
- can see UDH and even ADH
Tx: excisional bx, careful f/u
Papillary duct hyperplasia
Has papillary epithelial hyperplasia w/o cysts, or apocrine metaplasia (vs juvenile papillomatosis)
Secretory carcinoma
Rare in young girls; occurs mostly in adolescent men [?]
Subareolar, well-circumscribed mobile masses, resembling fibroadenomas
- solid microcystic (honeycombed) and "tubular" with milky intra- and extracellular secretions
-- extracellular secretions are usually much more abundant
- both intracellular and extracullular secretions are PAS (+)
Micro: minimal nuclear polymorphism, few mits, pale granular/vacuolated cytoplasm
- nucleoli are frequently prominent
- watch out for DCIS component (common)
Triple negative; S100 and alpha-lactalbumin (+)
All have balanced t(12;15)(p13;q25) combining ETV6 (a transcription factor) and NTRK3 (neurotrophin-3 tyrosine kinase)
- translocation causes Ras-Mek1 and pI3-Akt pathway activation
- secretions may be due to activation of gene controlling mammary growth factor
Tx: Breast-conserving surgery with axLN bx
Px: excellent / favorable
- in older pts, can met or recur (generally more aggressive)
Juvenile papillomatosis

Secretory carcinoma of the breast

Secretory carcinoma. Pathology outlines COW#8
http://www.pathologyoutlines.com/caseofweek/case20058.htm
Axillary Lymph Nodes
axLN's removed for staging purposes
The presence and size of the met must be determined
- classify as macro-/micromets or Isolated Tumor Cells (ITCs)
-- cutoff for micro-/macro is 2 mm, but micro should be larger than 0.2 mm
-- ITC is <0.2 mm and < 200 met cells
Determining the exact size of the met has lots of intraobserver variation
Mets usually appear similar to breast primary
Should not routinely stain for micromets or ITCs
- normal cells in LN may be positive to stains in addition to tumor cells (ie CAM 5.2 stains interstitial reticulum cells)
AE1/AE3 is preferred stain
Breast massage can displace breast epithelial cells, benign or malig
Nevus cell aggregates infrequently (<1%) found, which can mimic mets
- more frequent in pts c melanoma
Resemble dermal nevi, c oval epithelioid cells c pale cytoplasm and in clusters
- may appear spindly, like a blue nevus
Nevus cells (+) S-100 and CK negative, vs met breast ca cells (S-100 negative)
Nevus cells can co-exist in same node as mets, so be careful!
Silicone (implant leakage or injection) can travel through lymph and cause reaction in axLN
- light refractile (non-polarizable) material found in cytoplasmic vacuoles
Benign inclusions in breast can be glandular, squamoid or glandular-squamoid mix
- look for MECs to show inclusion is benign (though can be absent in Mullerian-type glandular inclusions [will be WT-1 and PAX8 (+)])
Treatment Effects
Neoadjuvant tx does not improve survival, but reduces amount of breast tissue needed to be revoved, thus making it more cosmetically beneficial
Radiation causes epidermal atrophy and telangiectasia
- fat necrosis can look like carcinoma
Atypical scattered epithelial cells c dark nuclei, vacuoles in cytoplasm, inconspicuous nucleoli that protrude into lumen
- carcinoma cells will be more uniform than these atypical cells
Chemo tx shows atrophy, lobular sclerosis, and, similar to radiation, nuclear atypia
- treated tumor area will have inflammation, hemosiderin, and lack of normal glands
- can have cytoplasmic vacuoles
Must find left over tumor cells, which may have very red cytoplasm c vacuoles, large and multiple nuclei
- may be confused c histiocytes (get CD68)
LNs may become completely fibrotic, but should still be reported as a lymph node
Response to chemo must be graded
- important prognostic indicator!!!
Can use Miller-Payne system (Grade 1: no change in tumor cells; Grade 5: no tumor cells visible), or Residual Cancer Burden system (Grade 1: no cancer; grade 4: extensive residual disease
